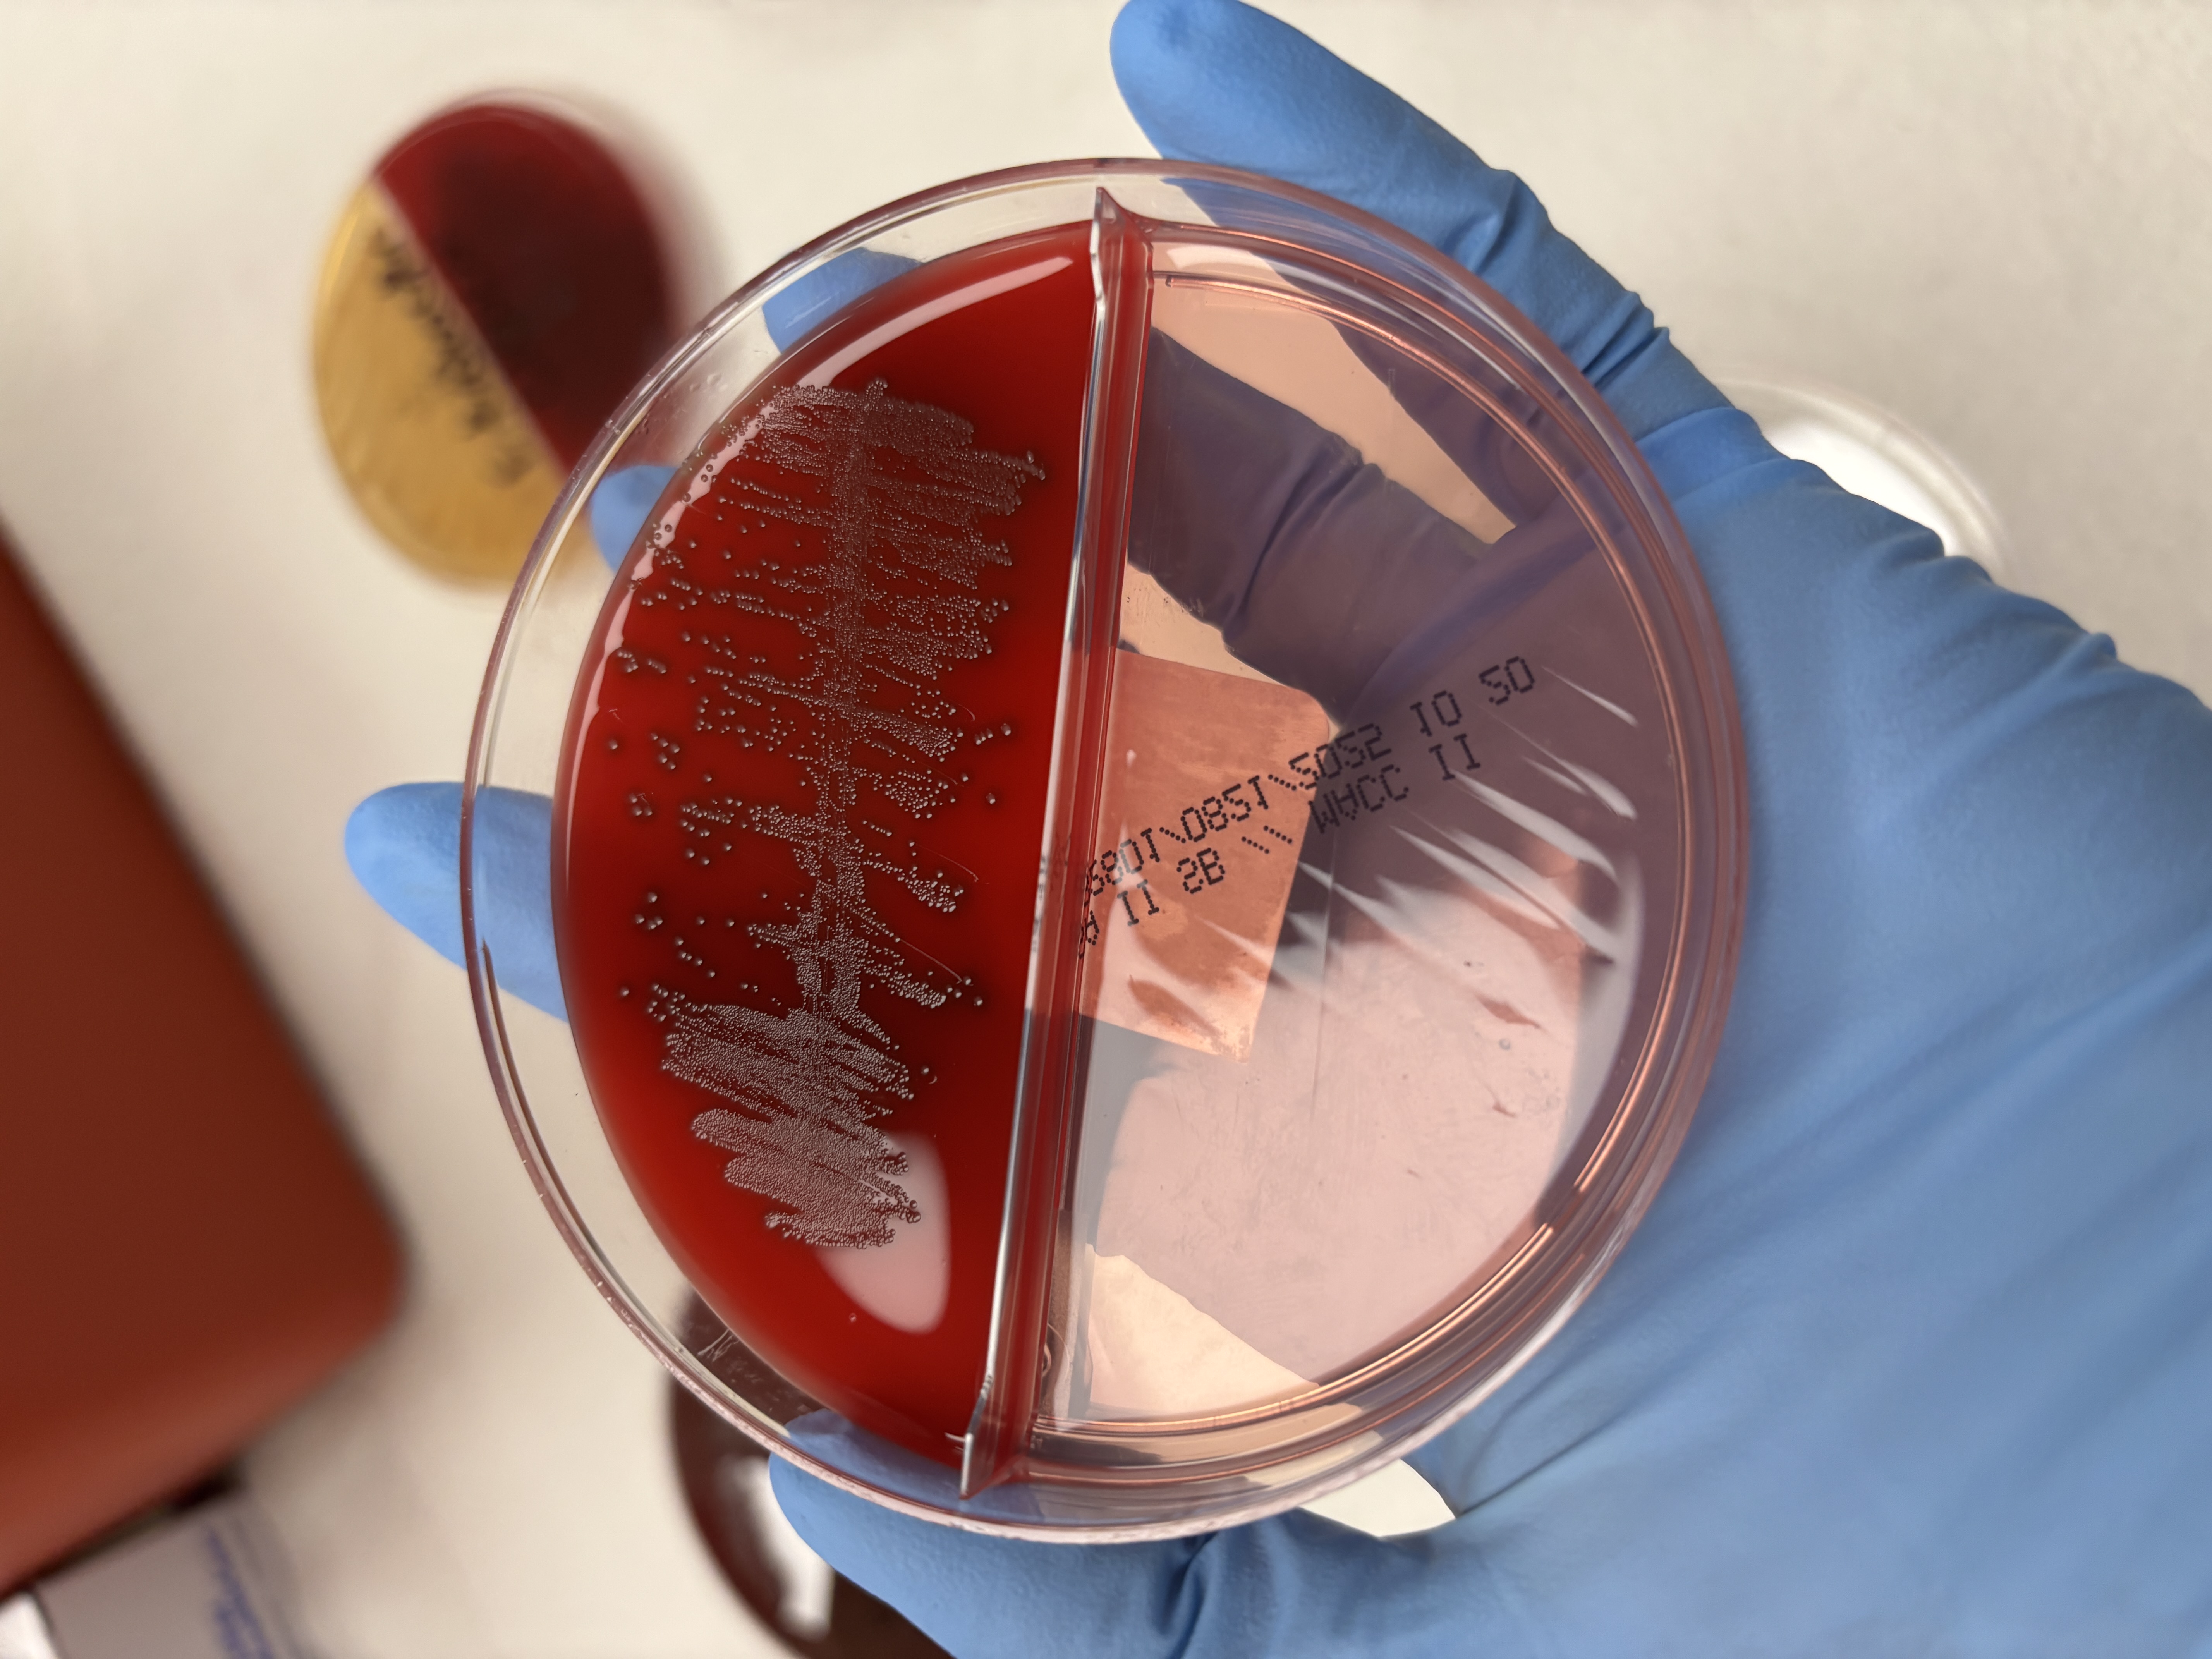
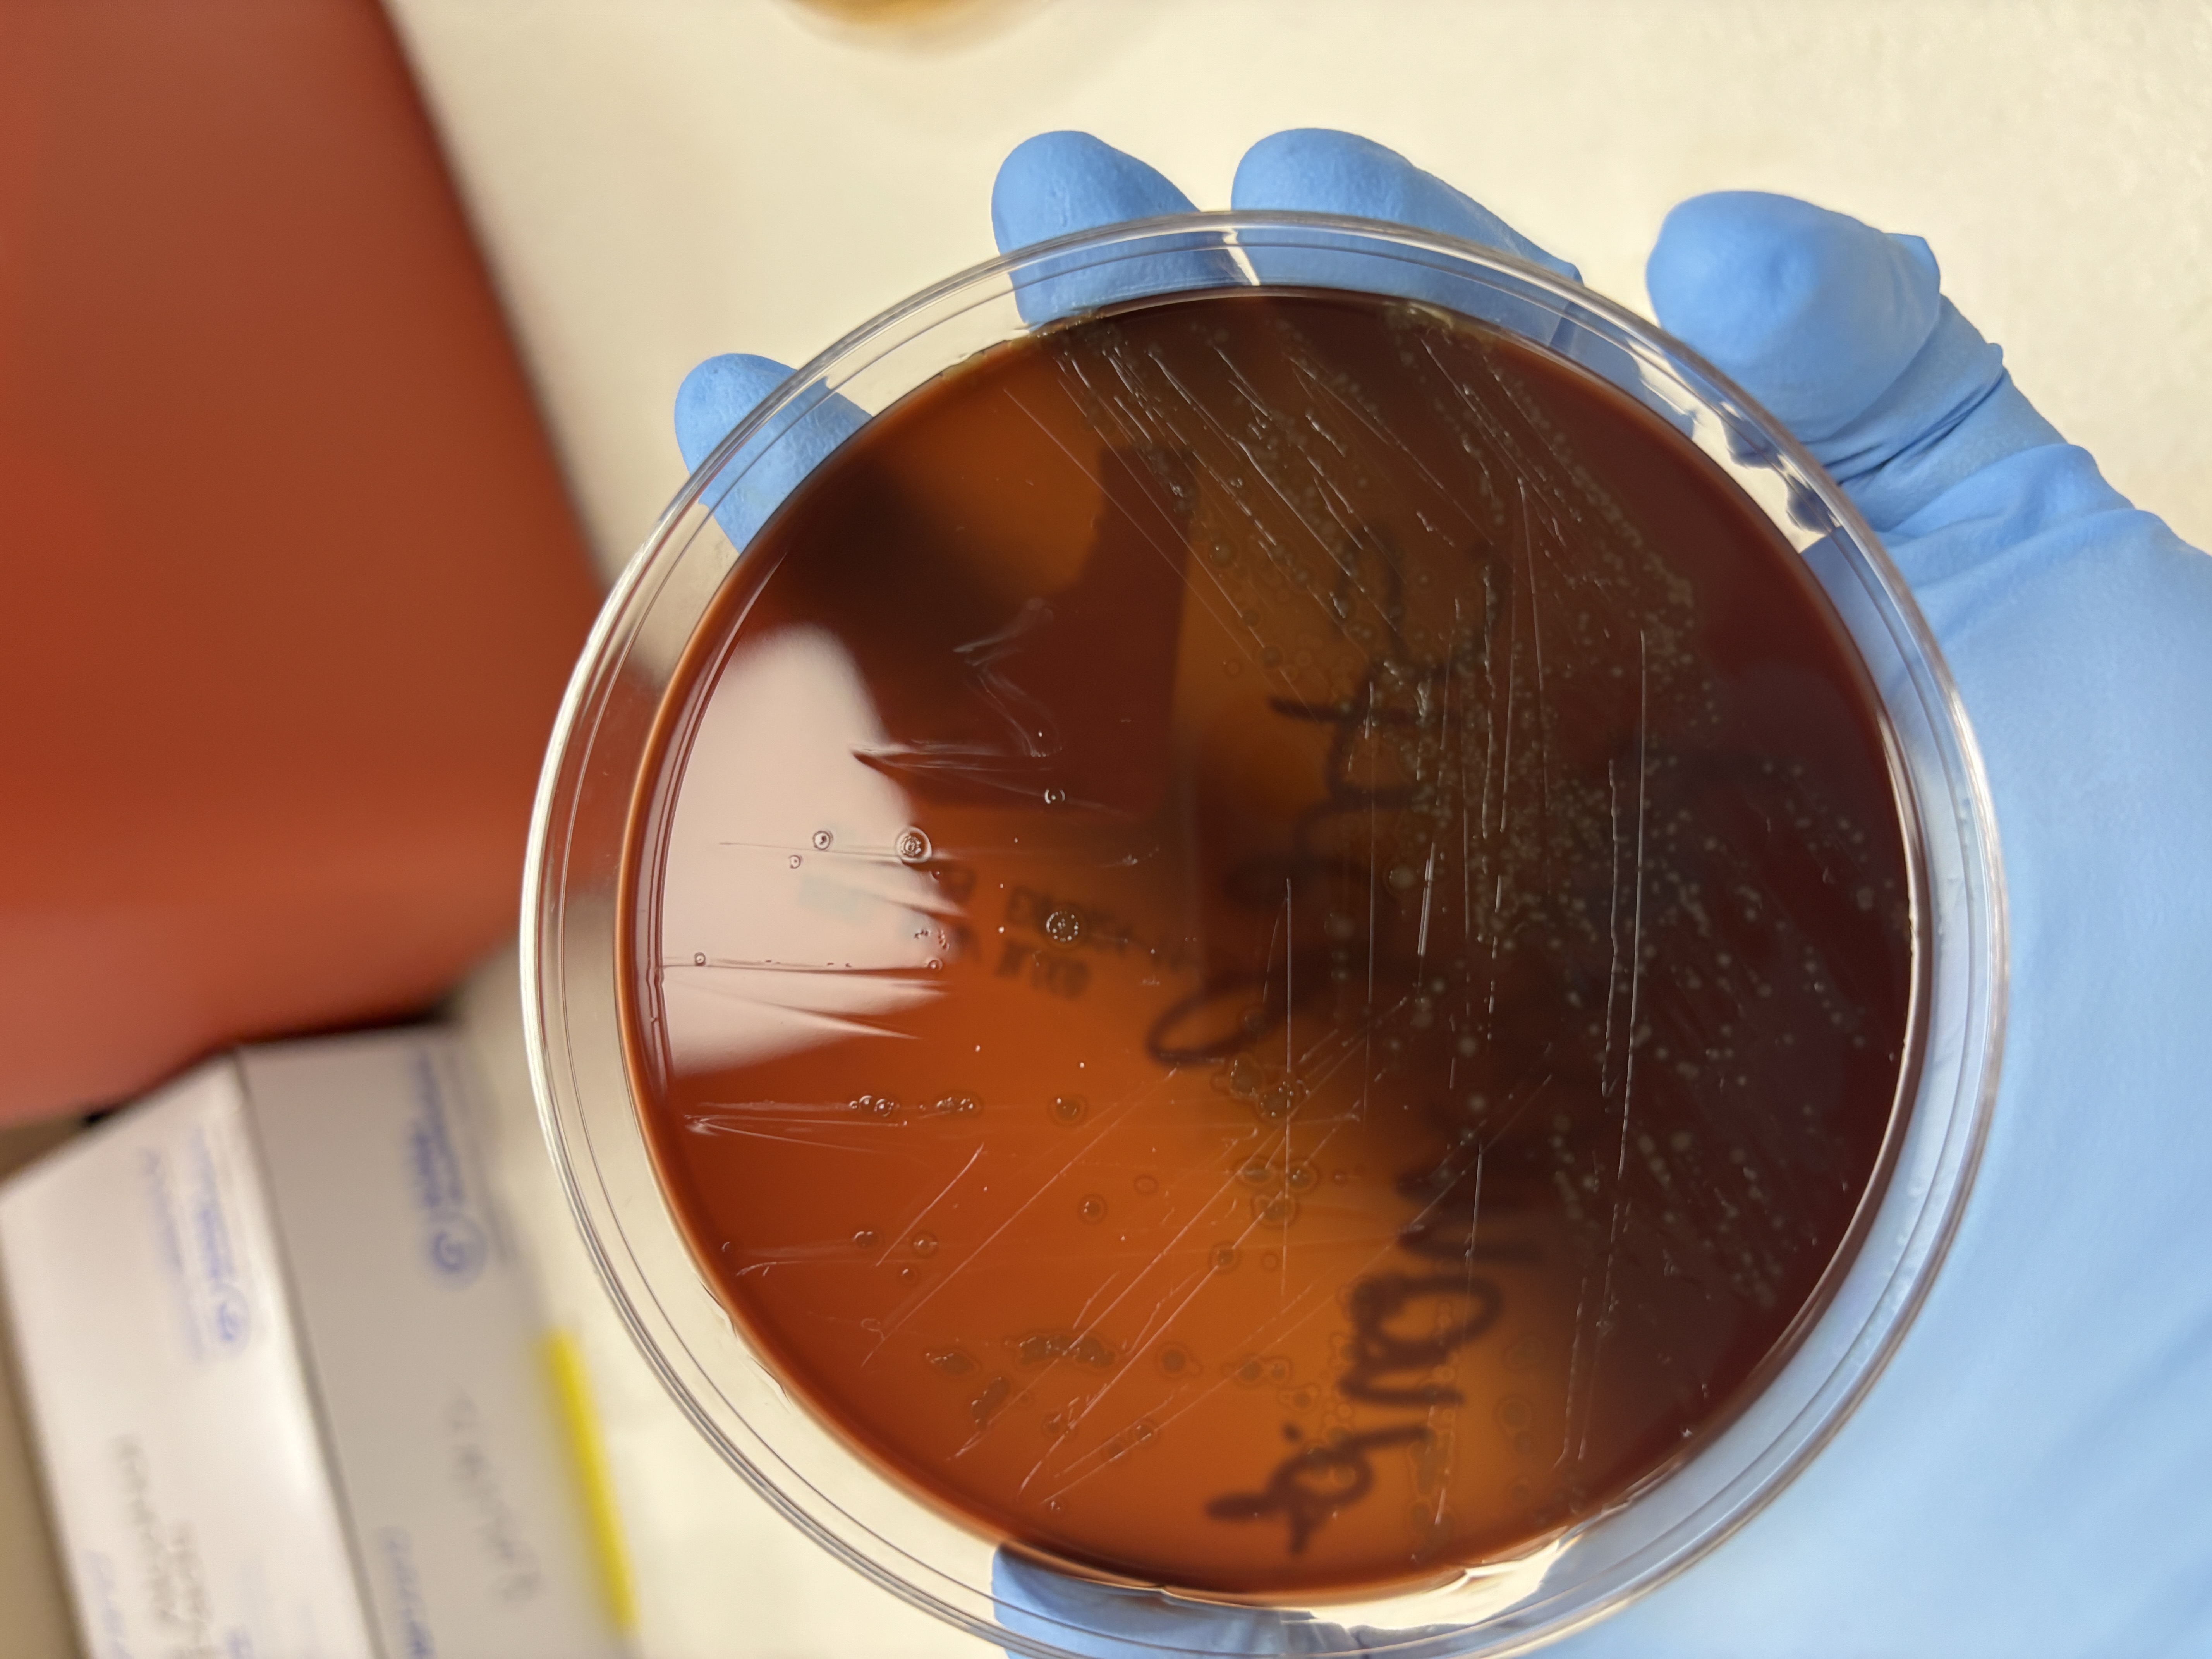
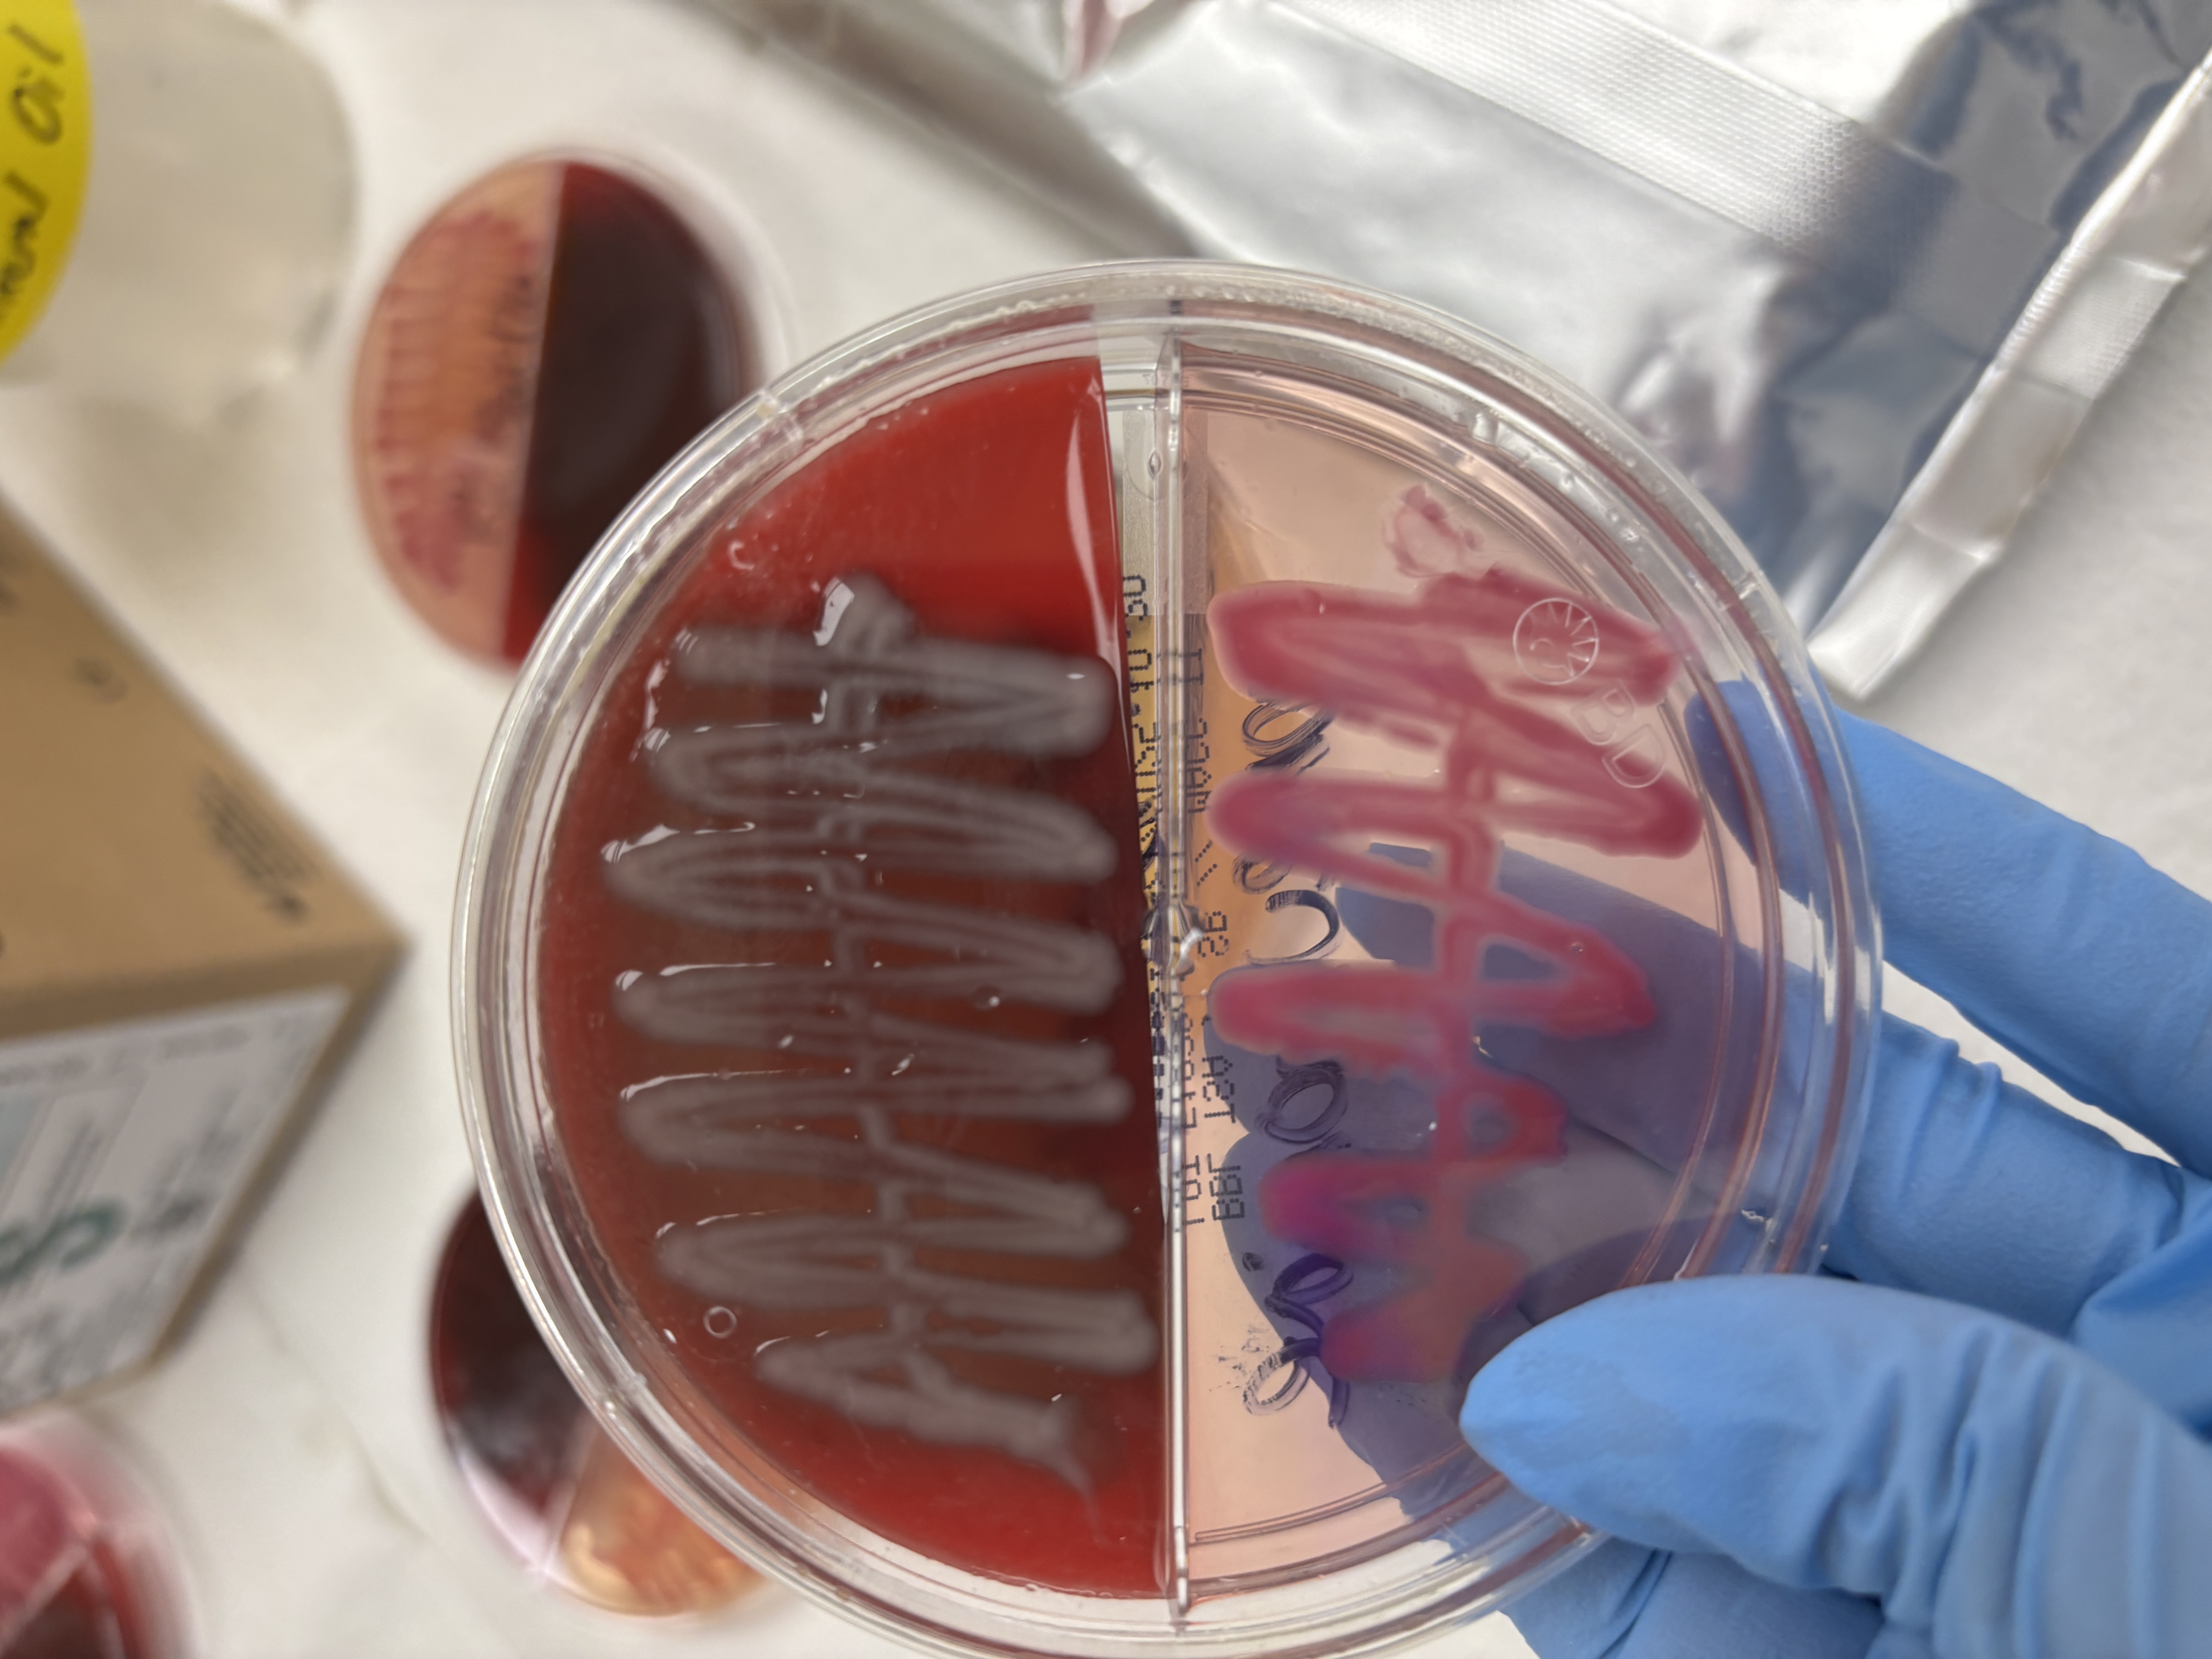
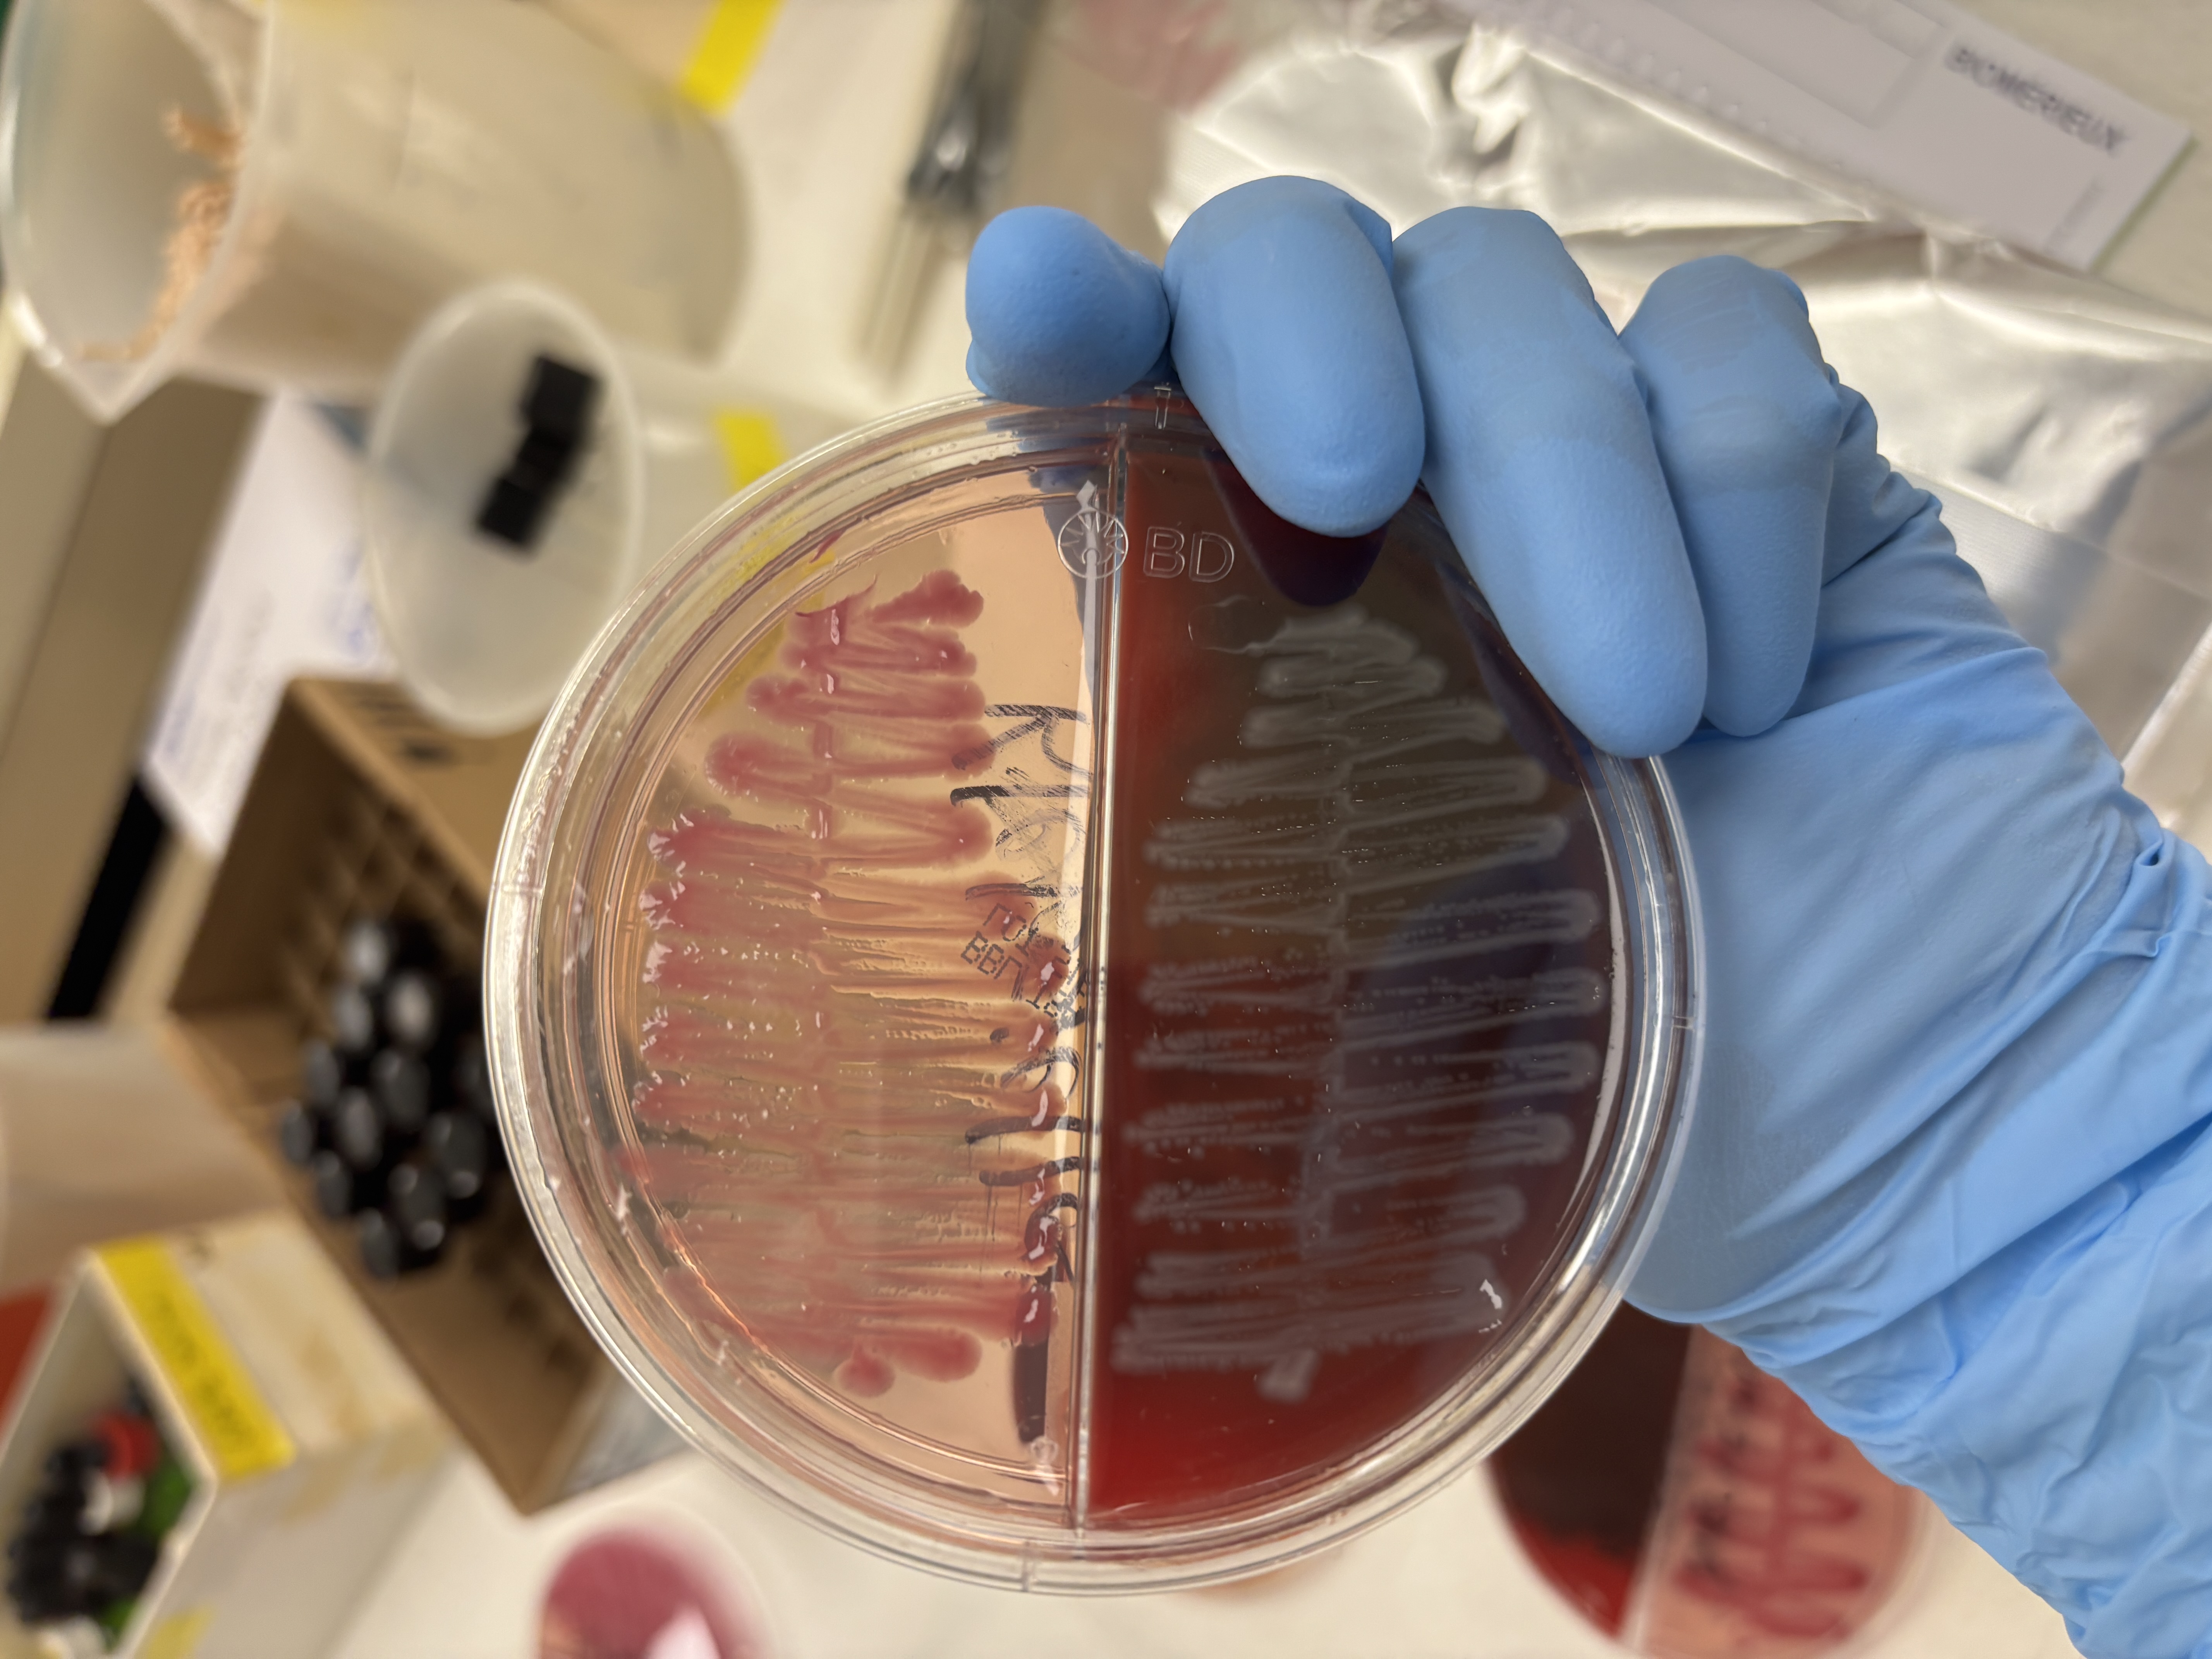
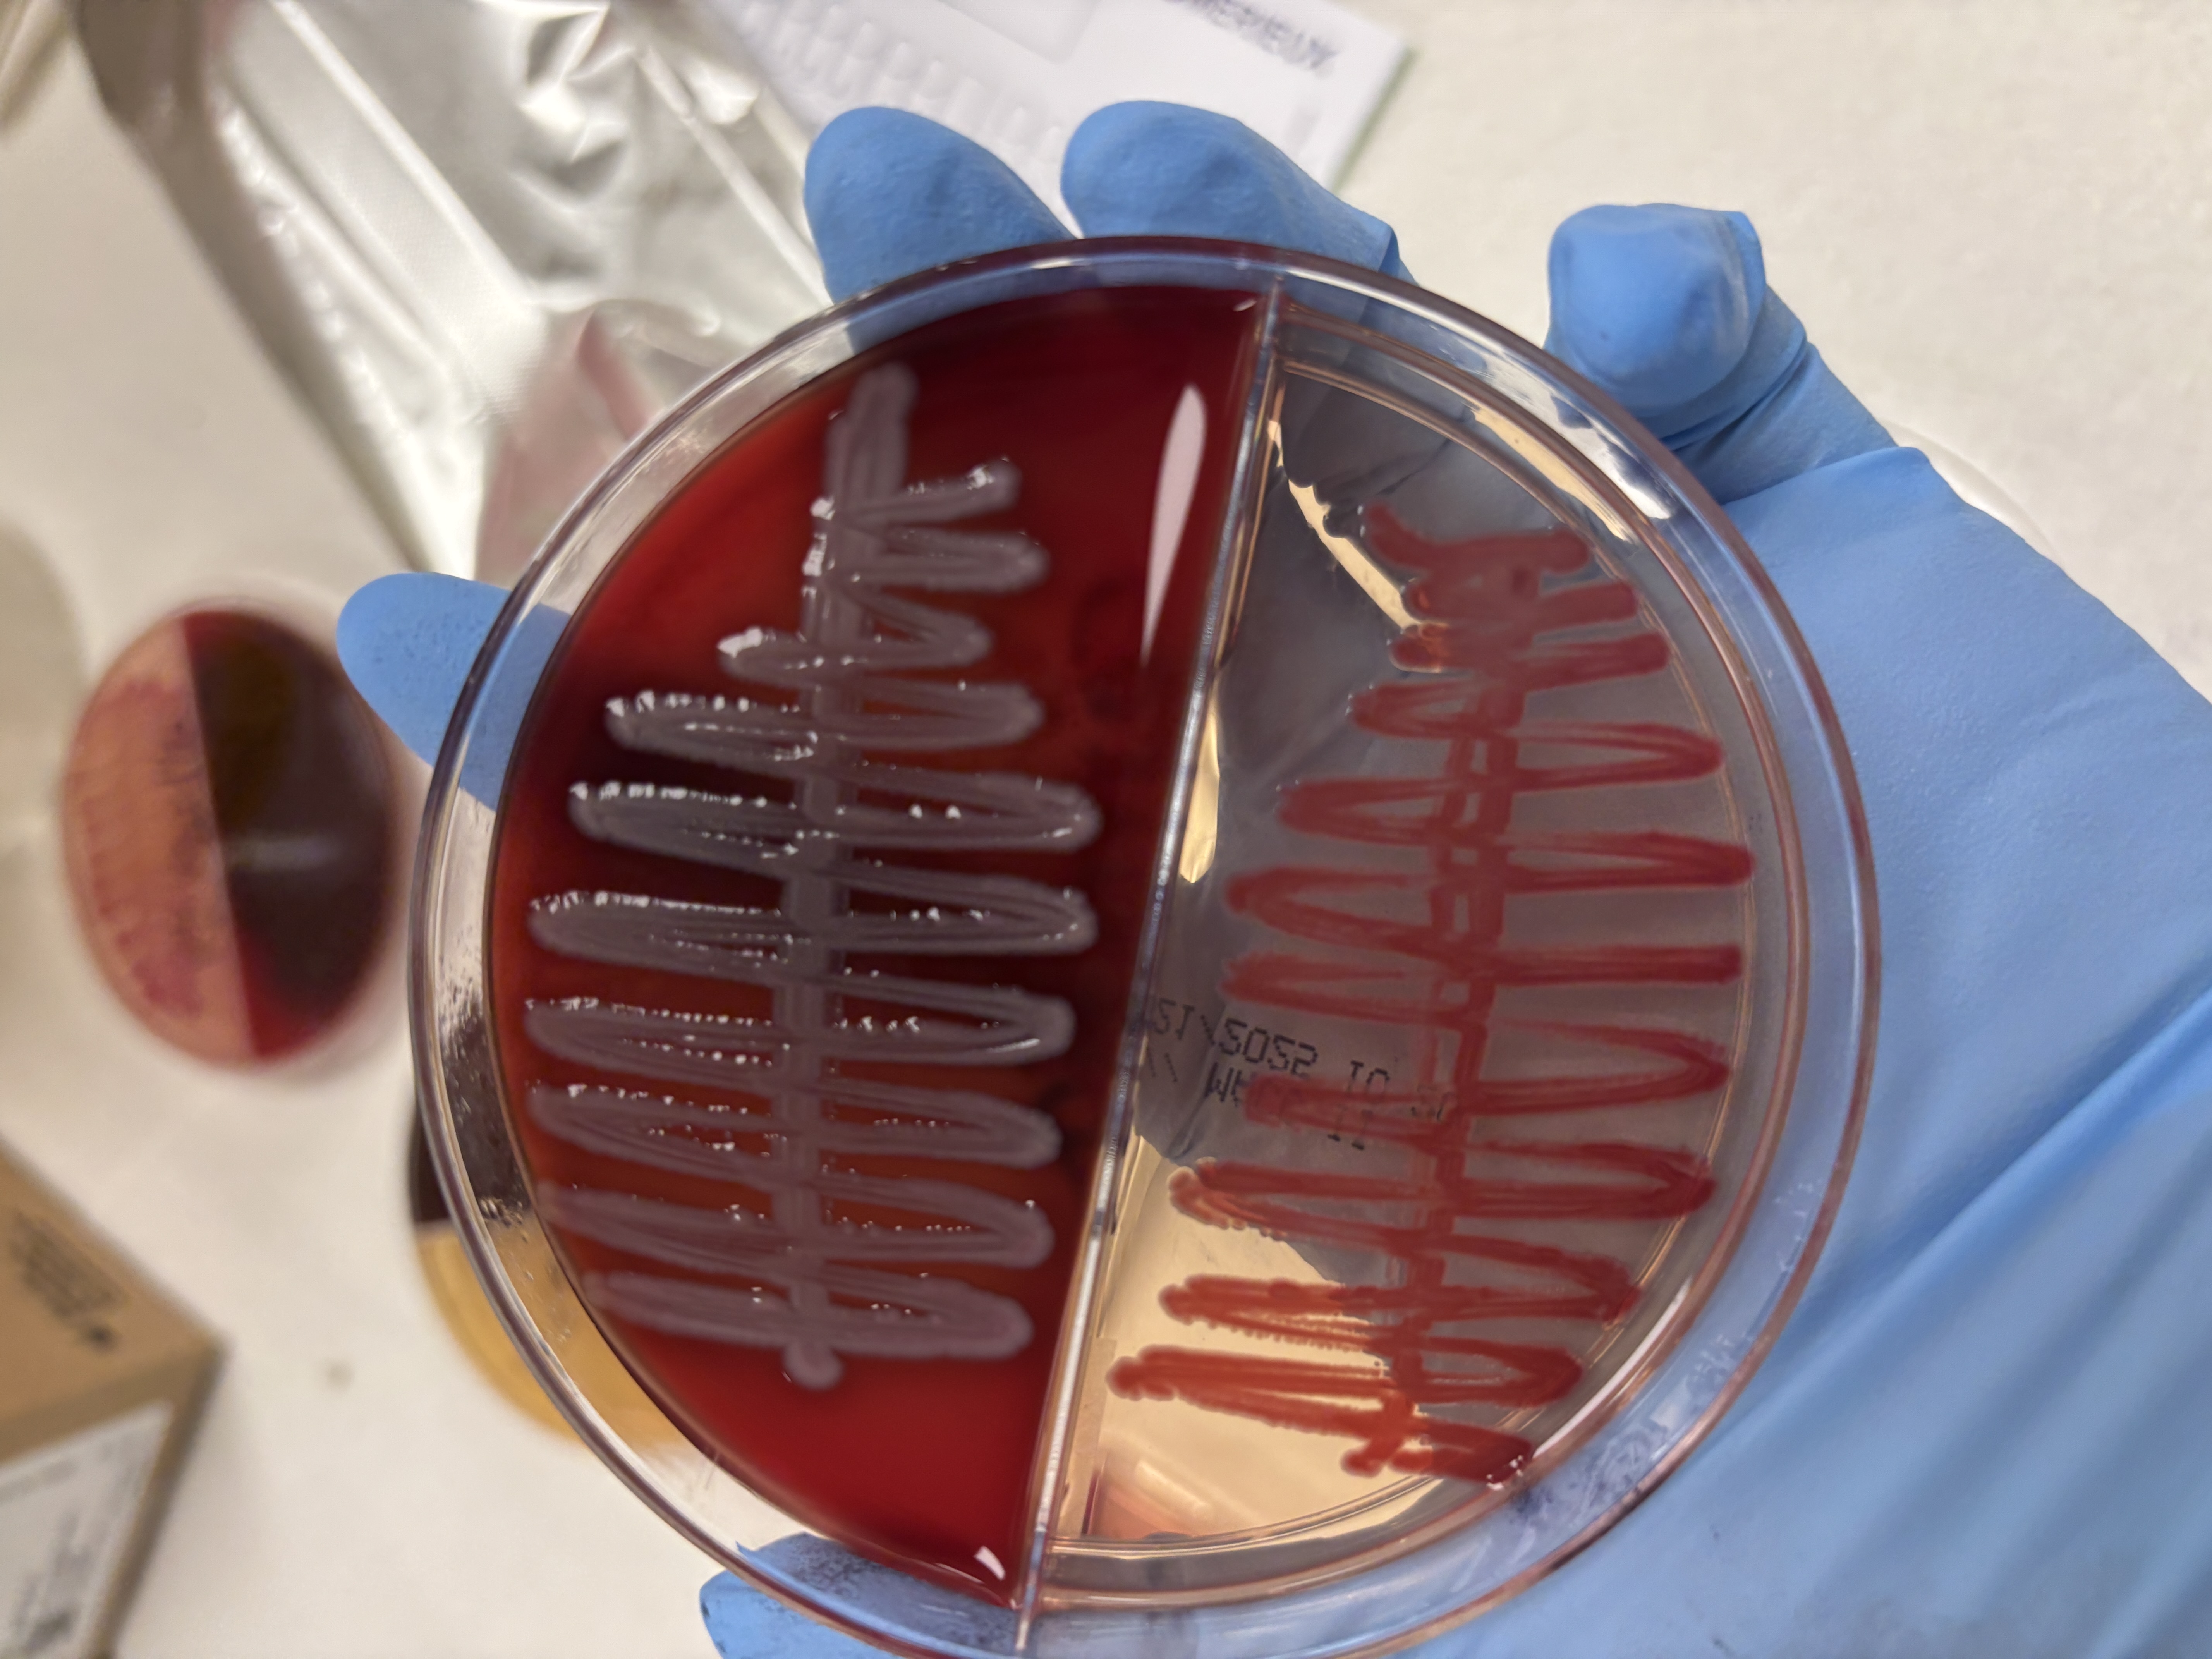
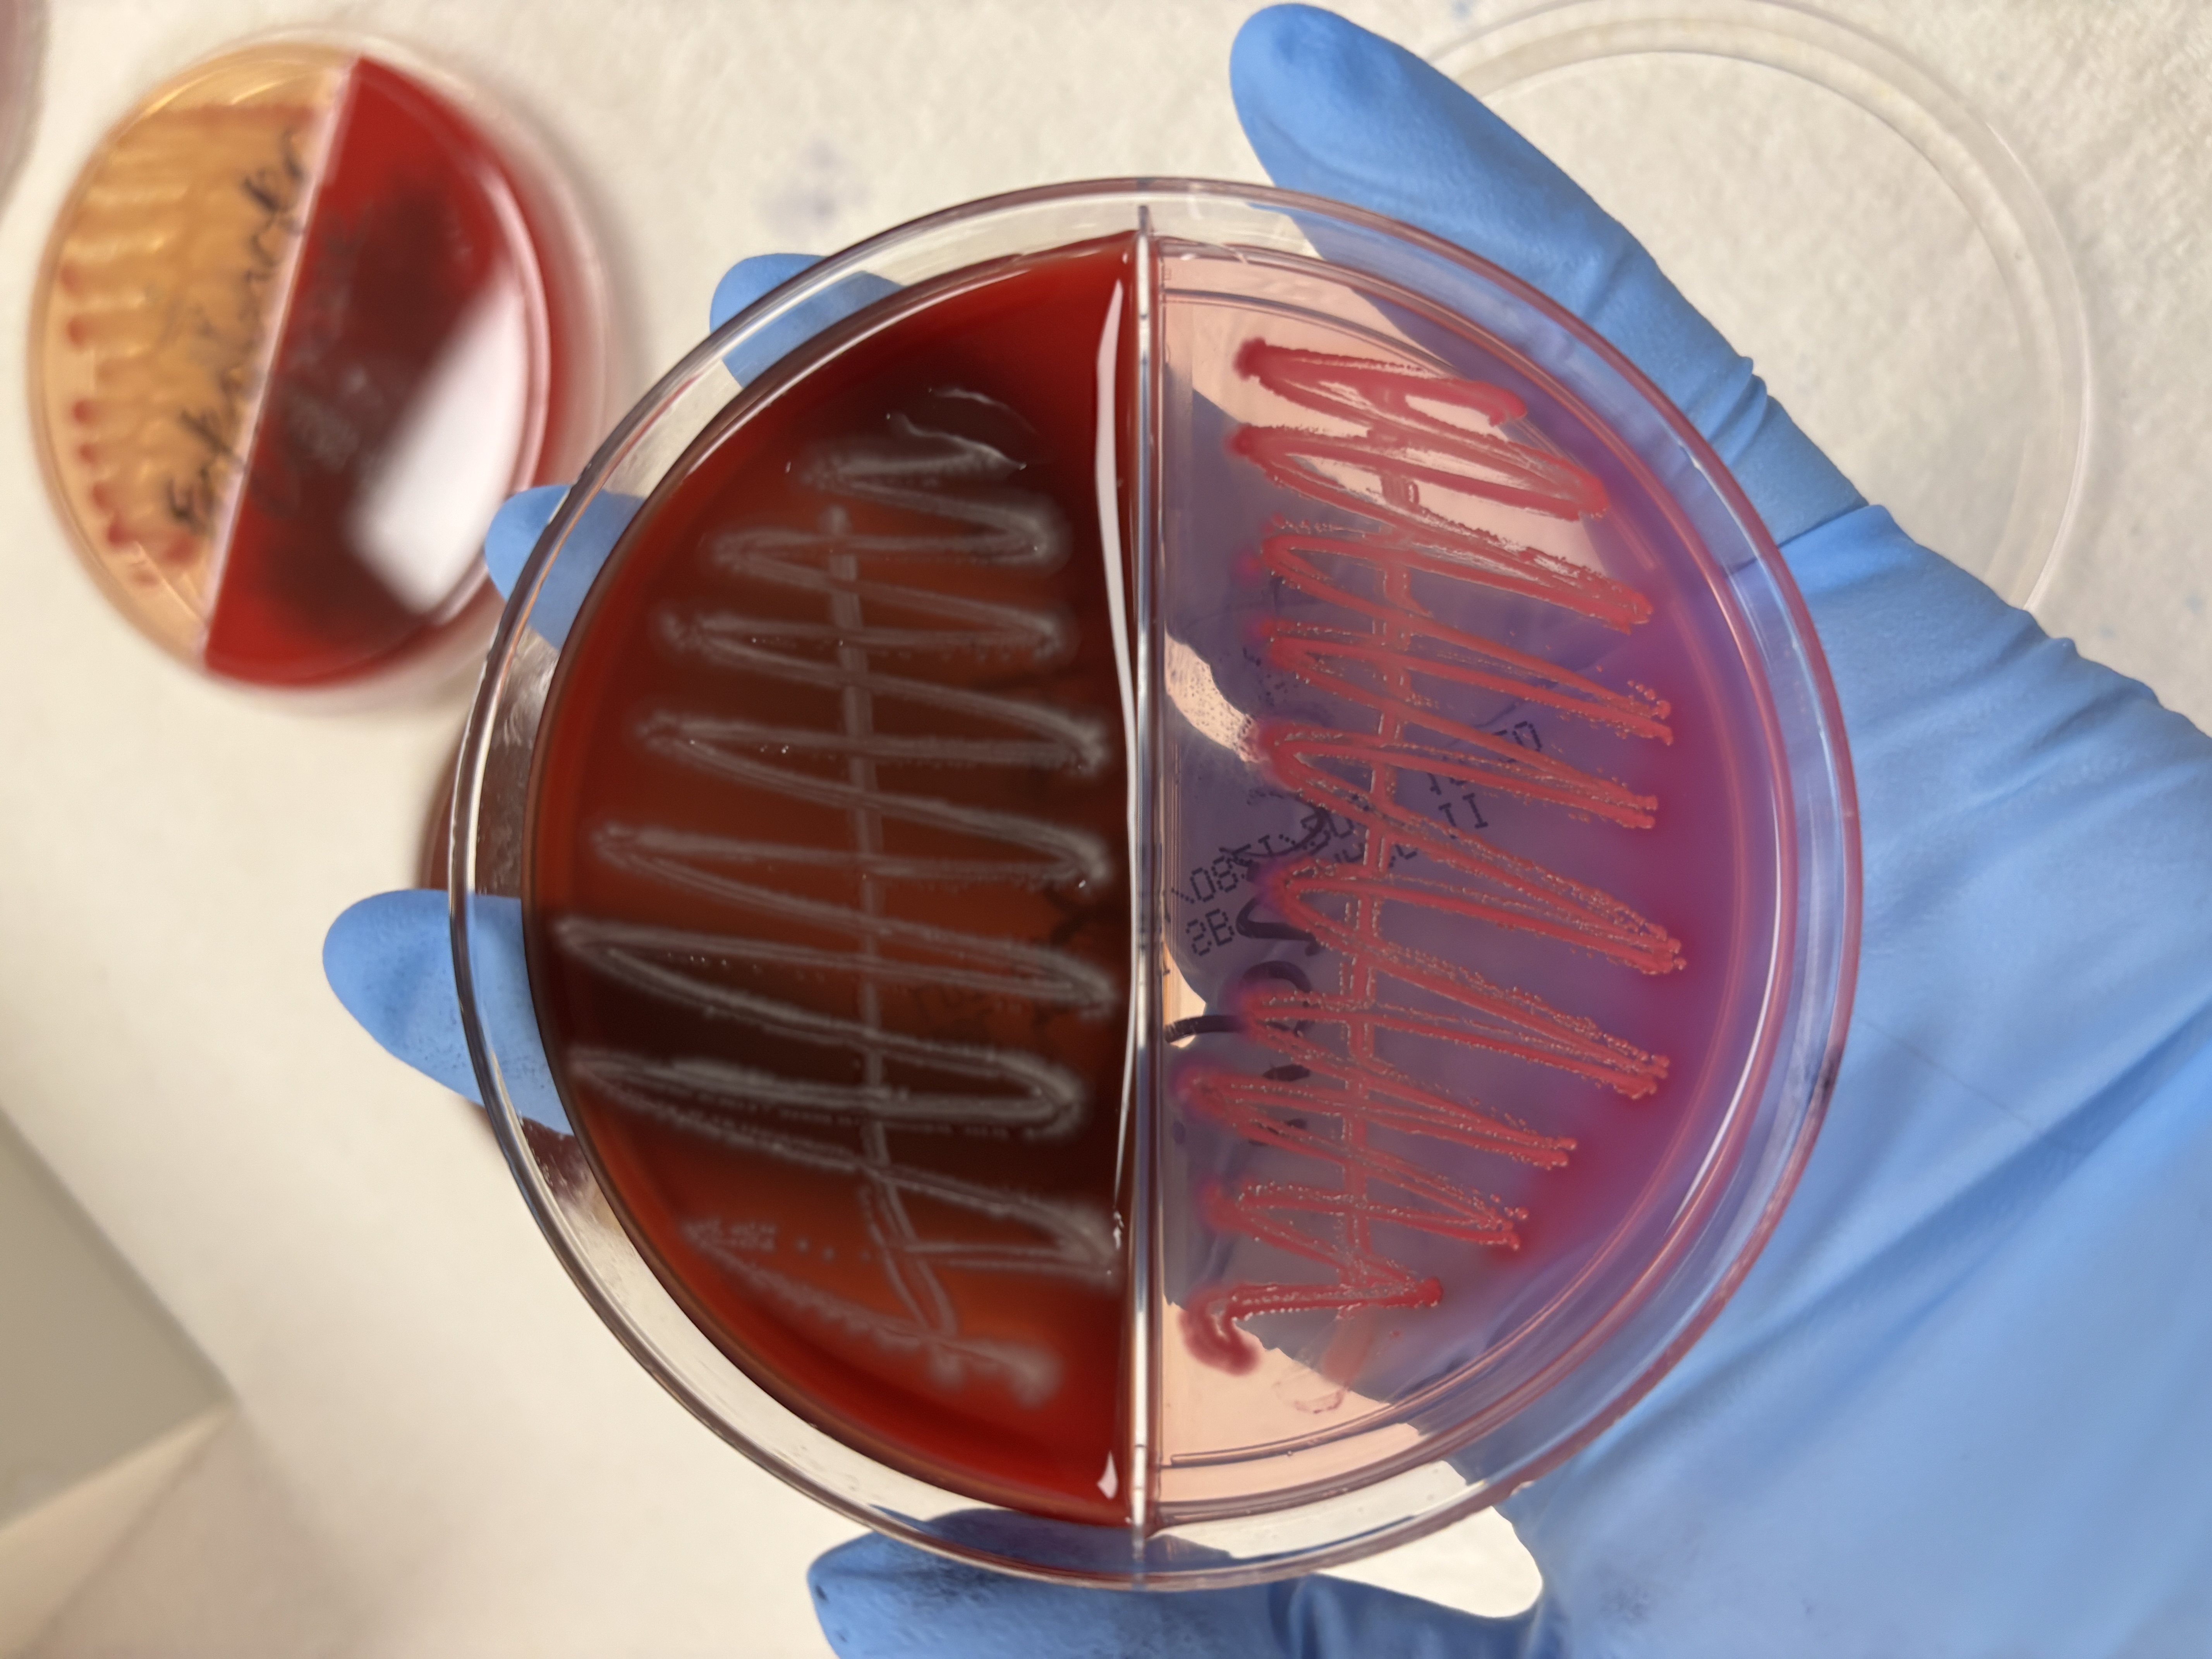
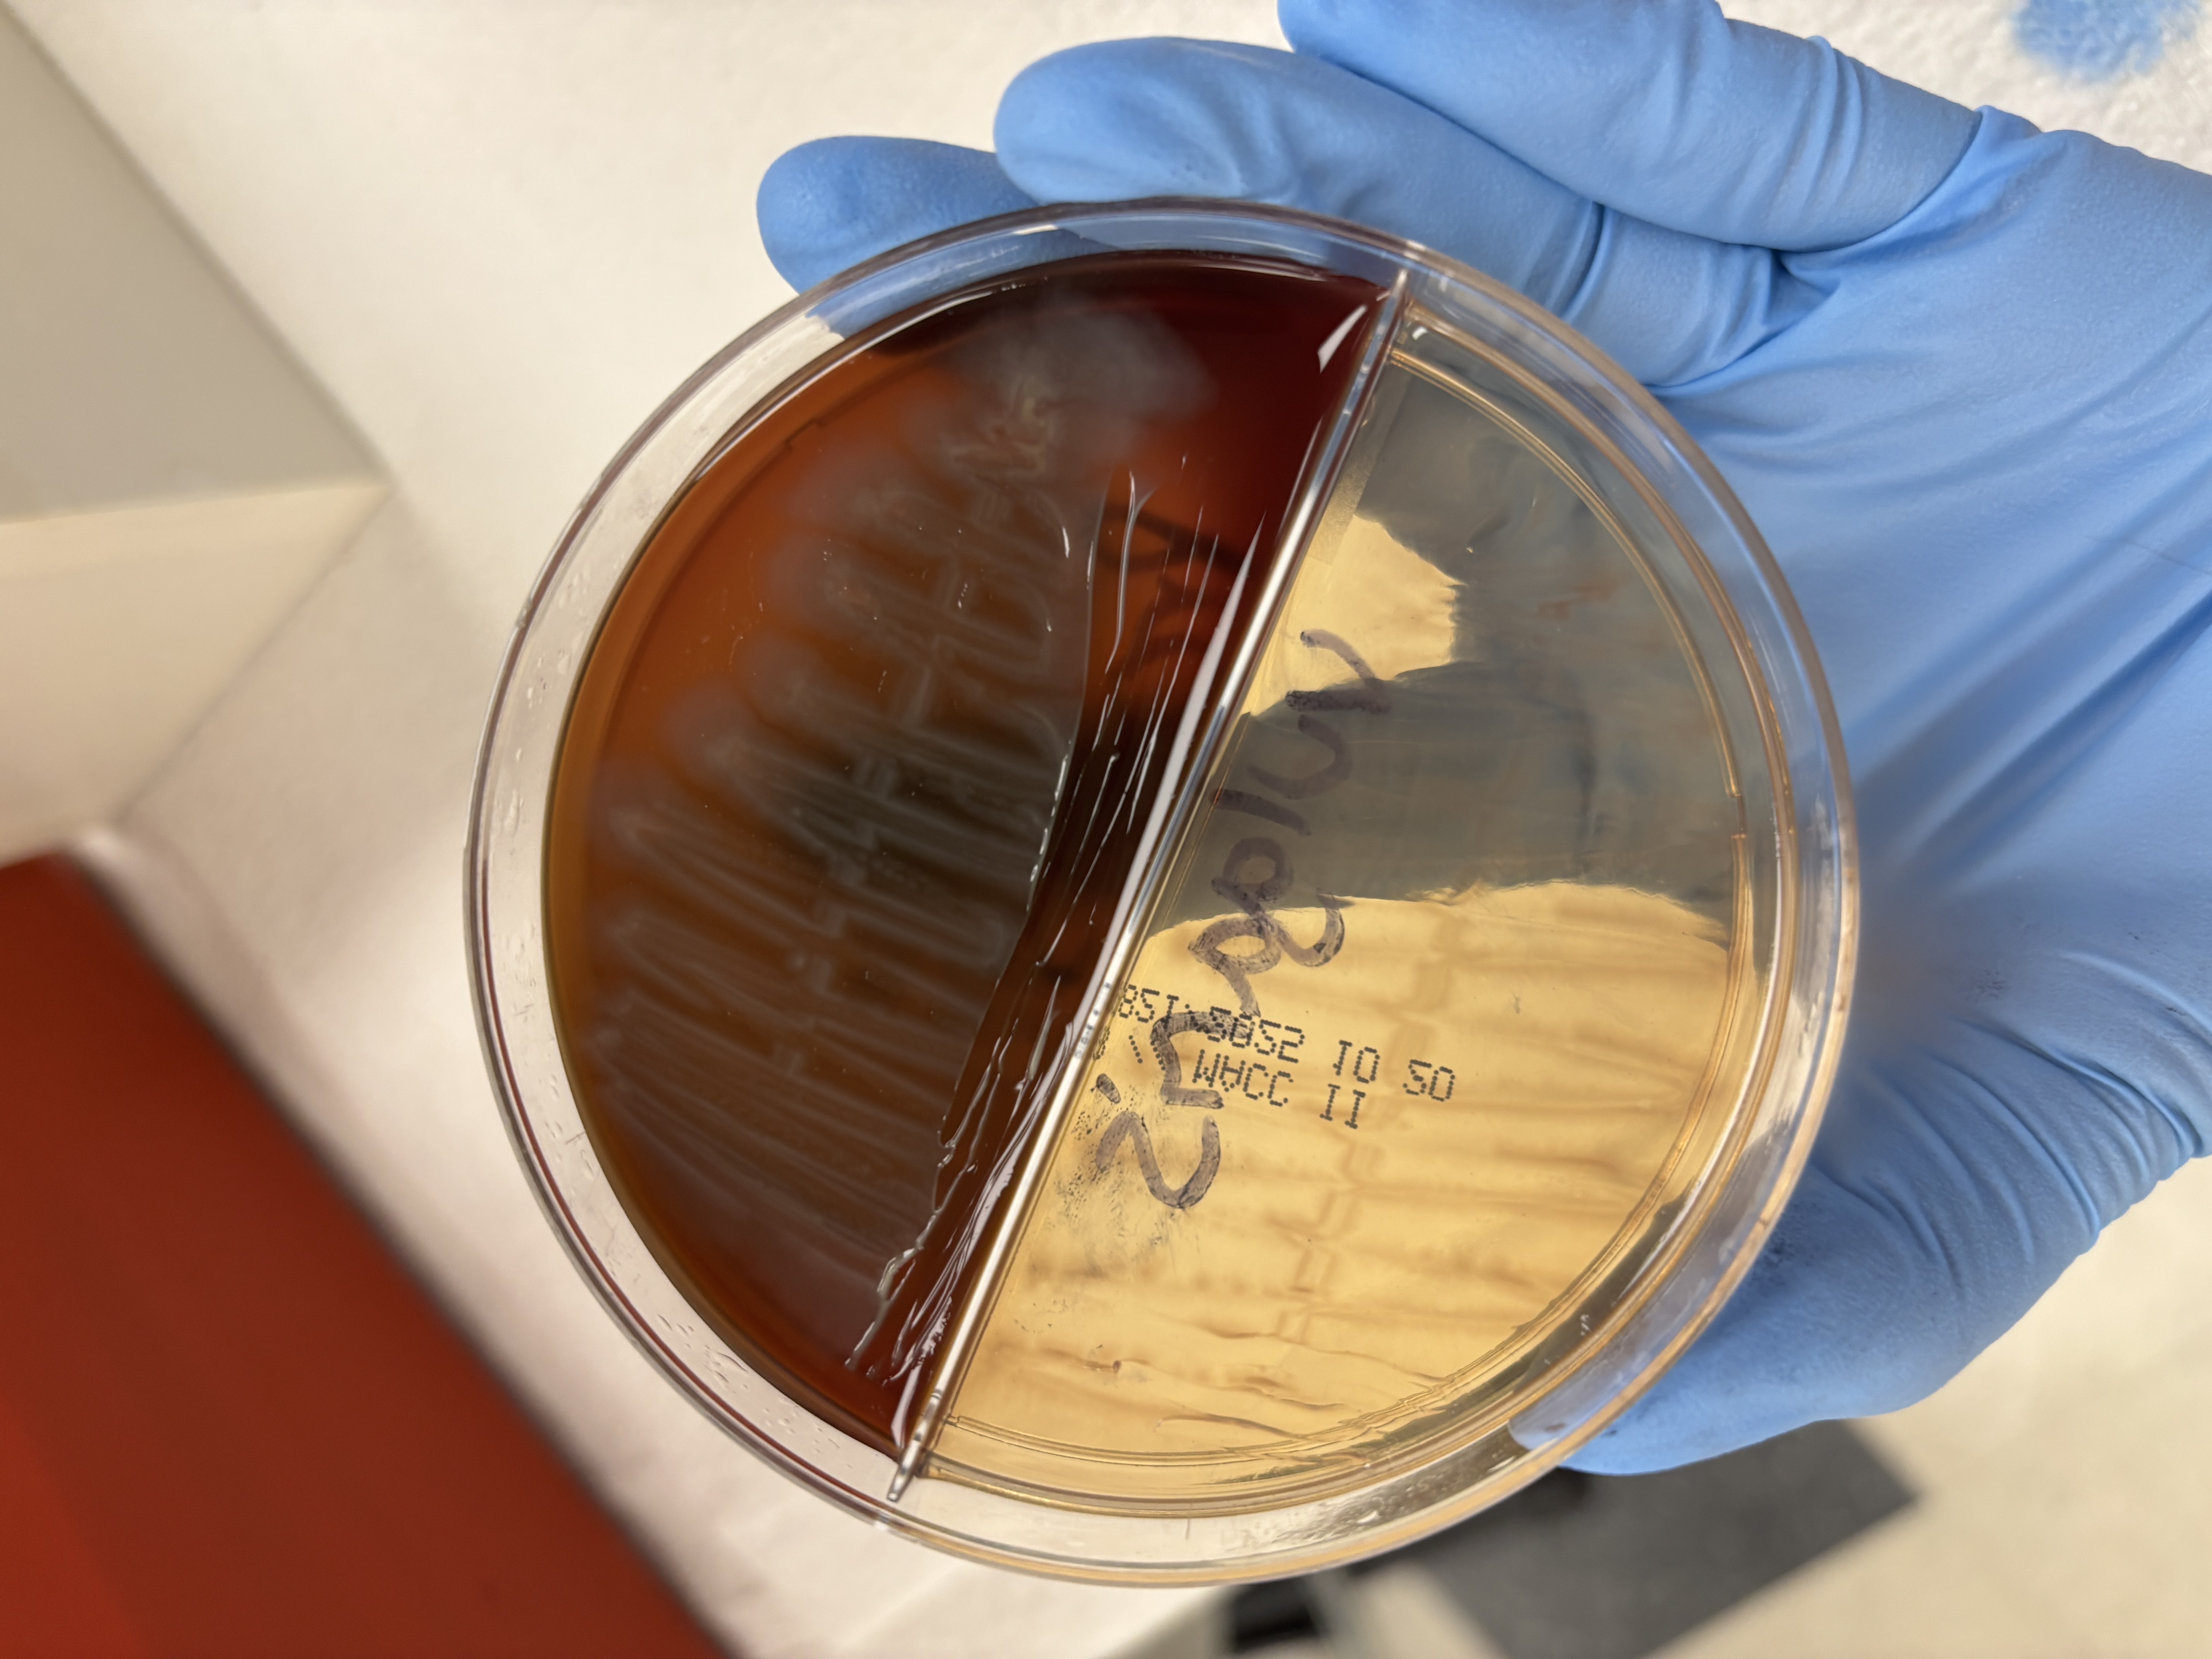
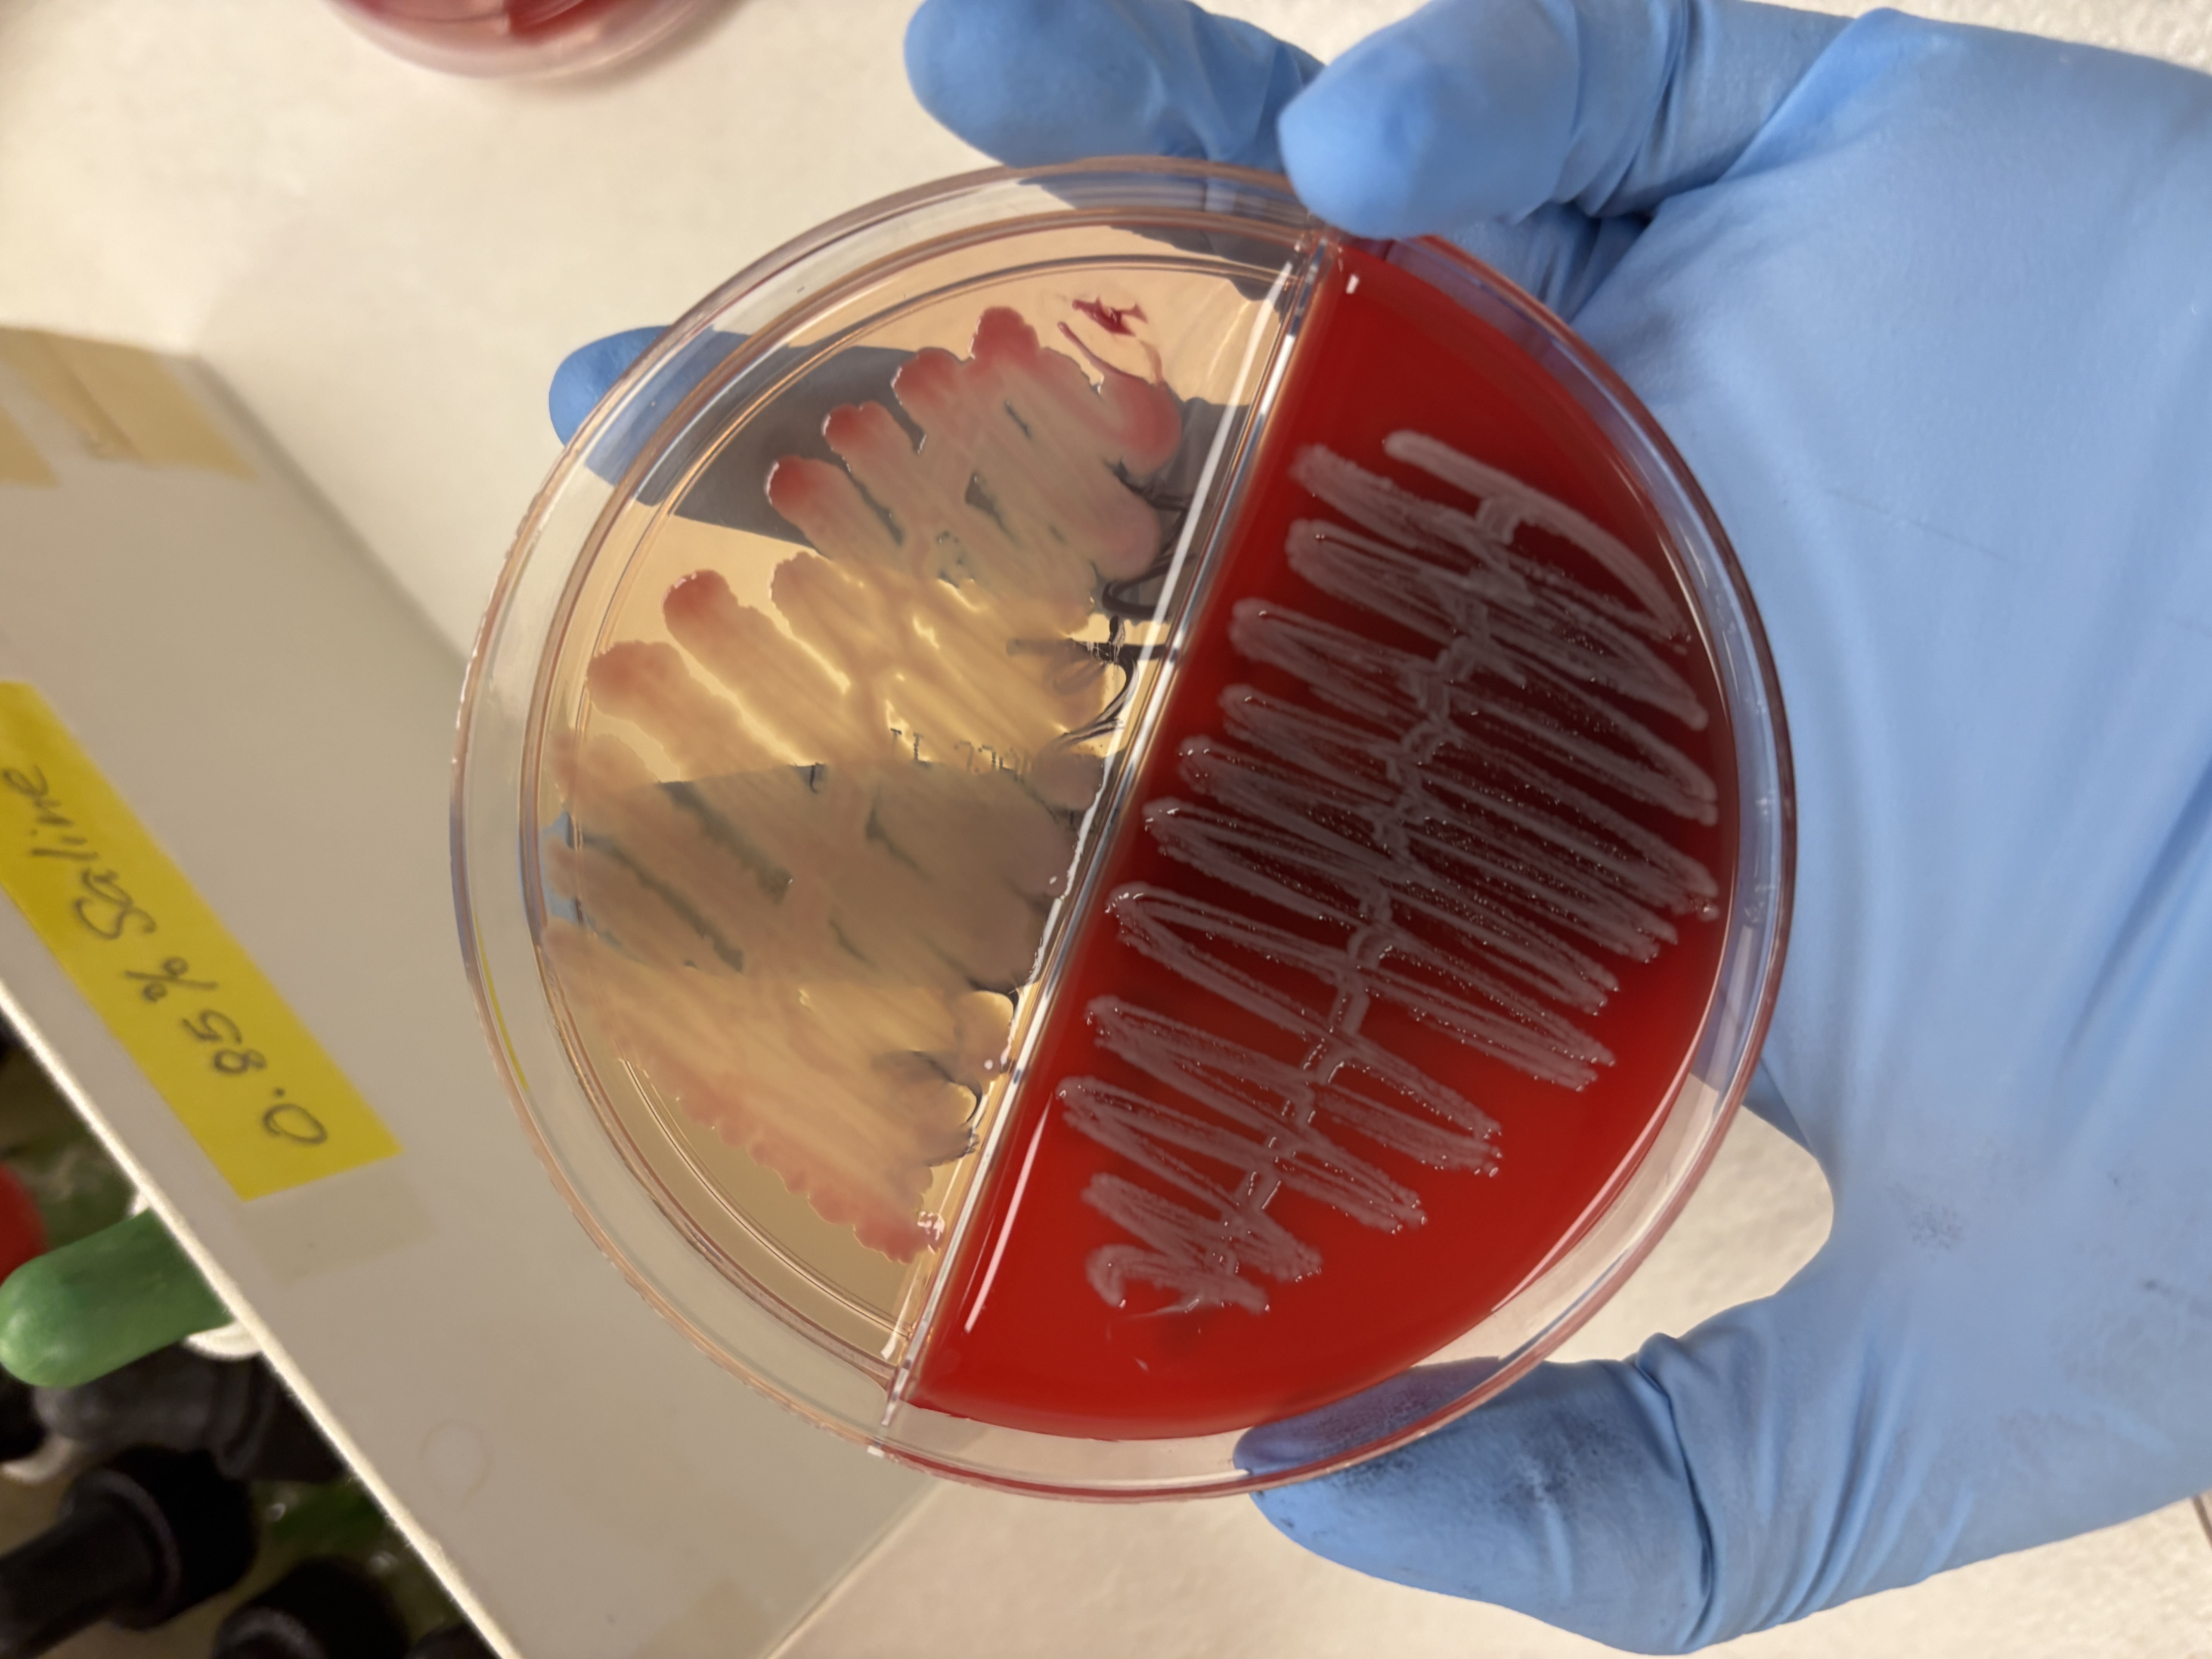
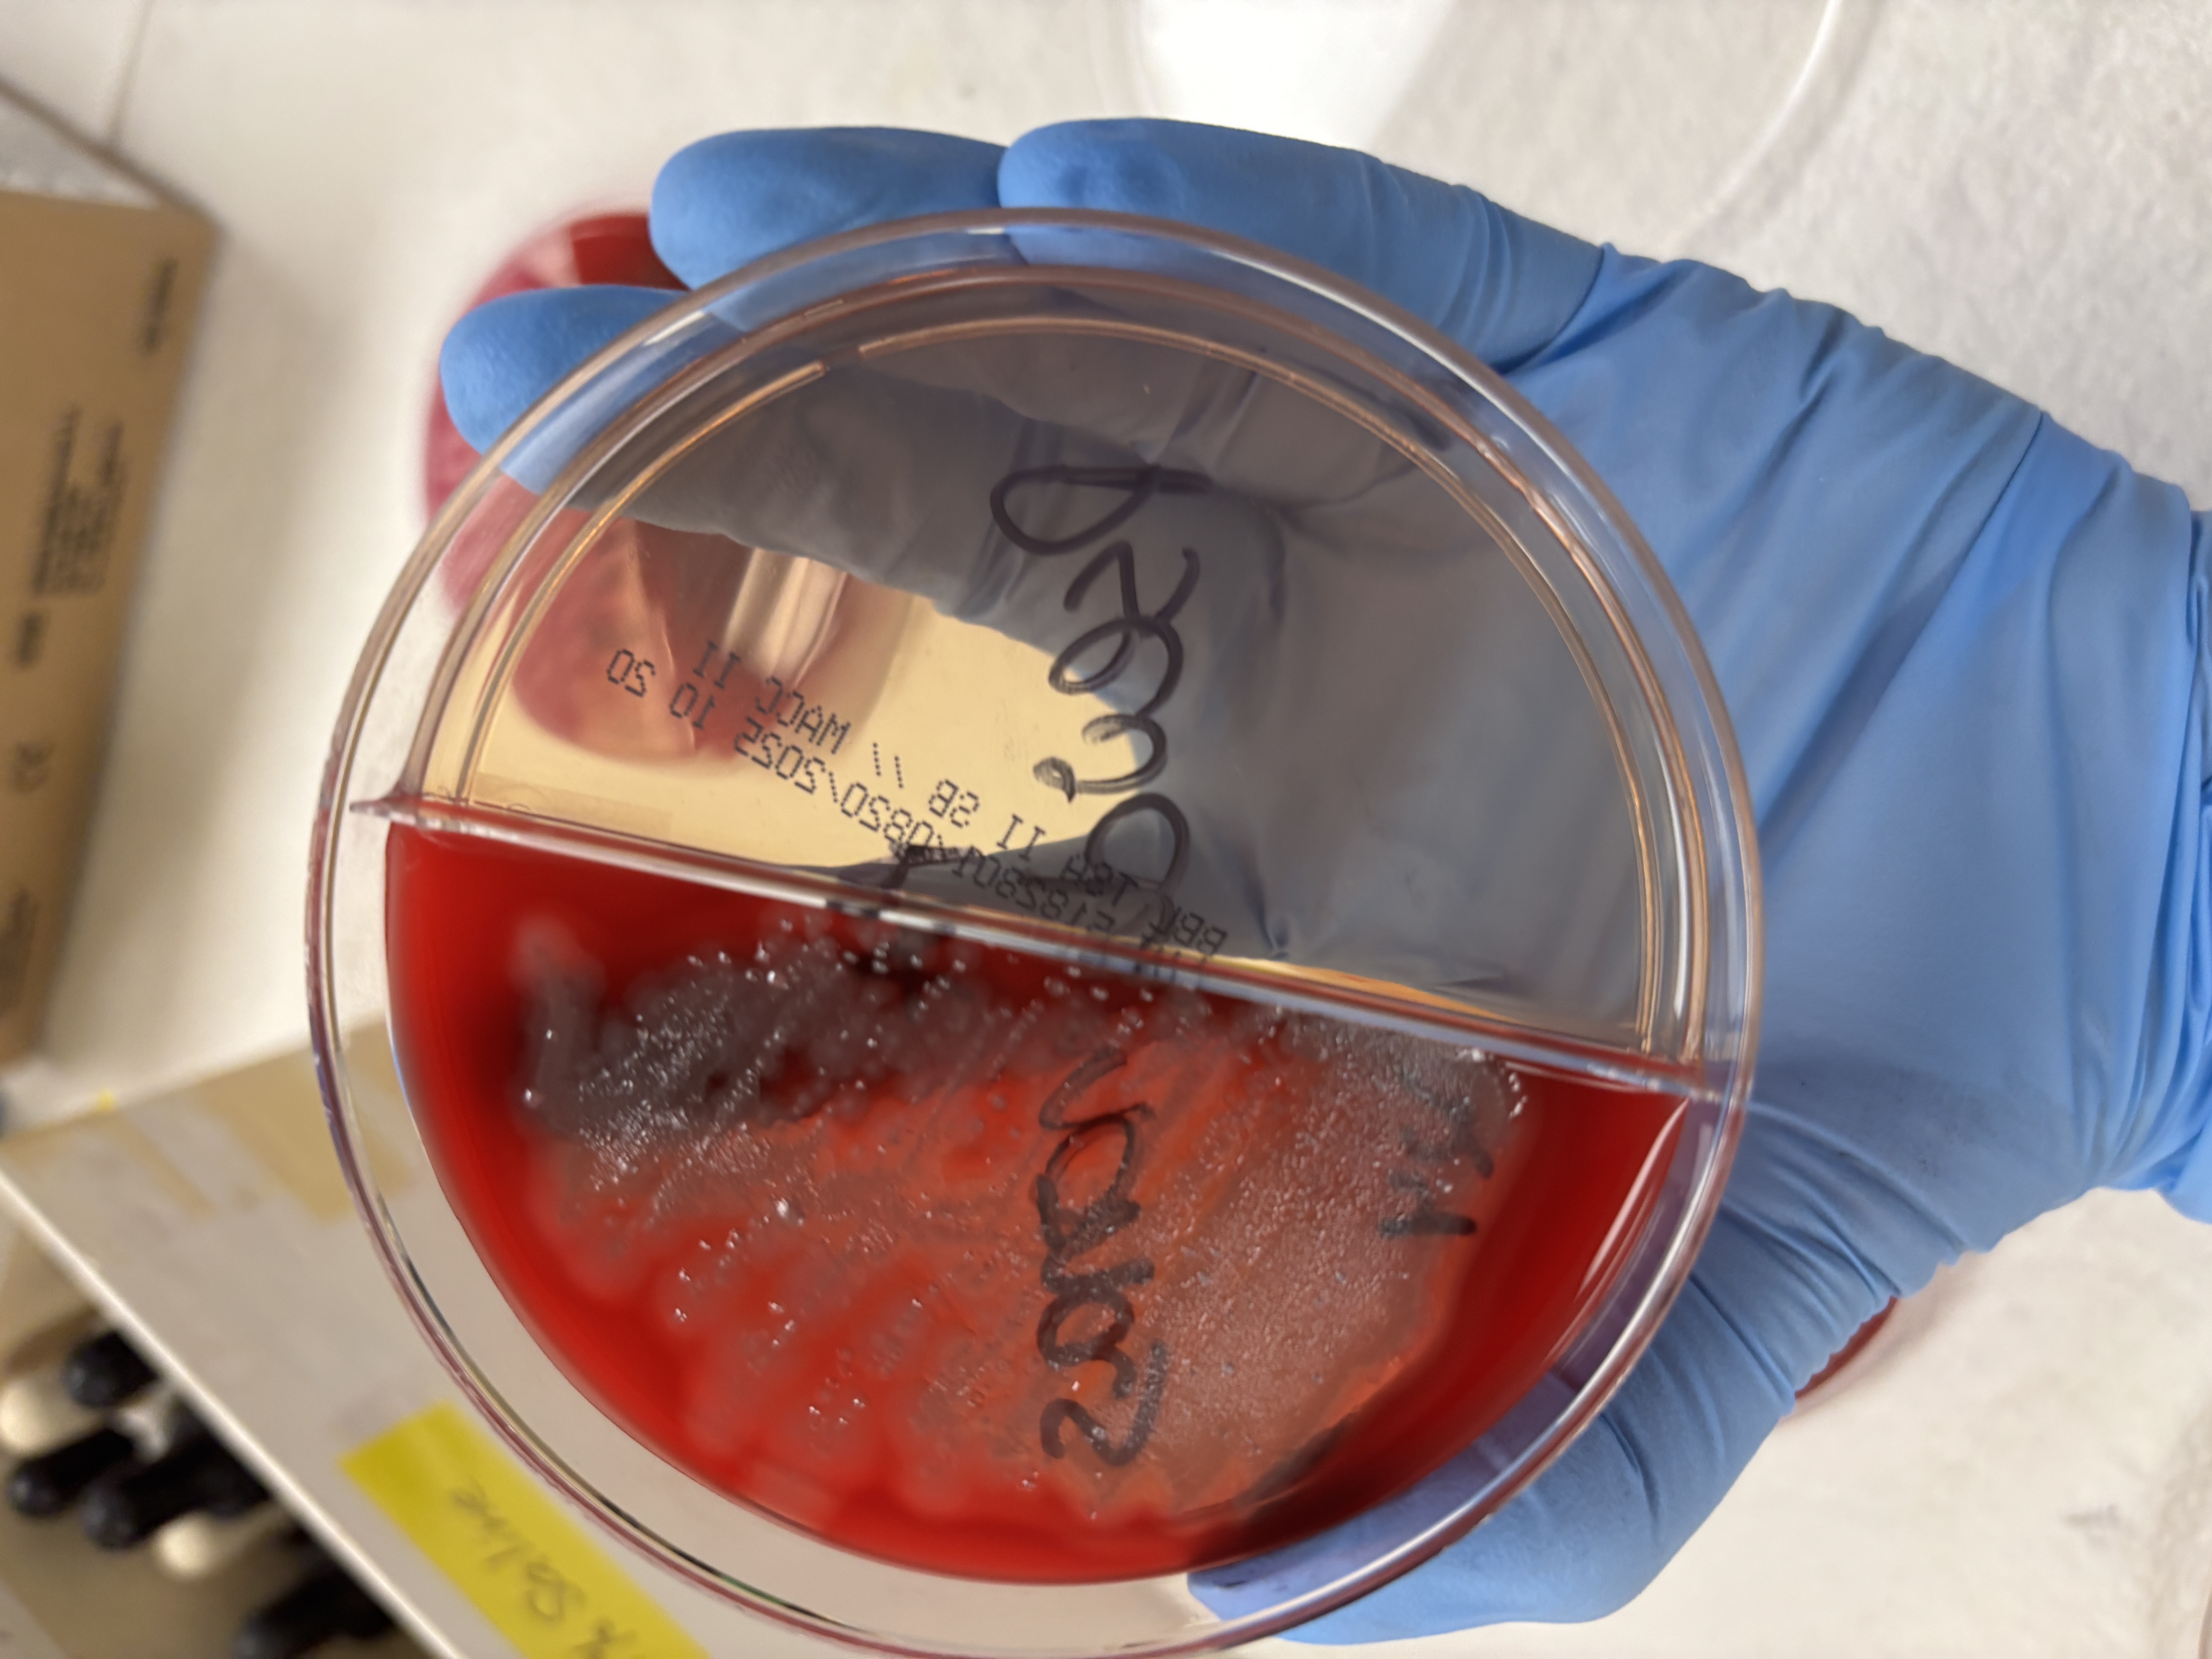
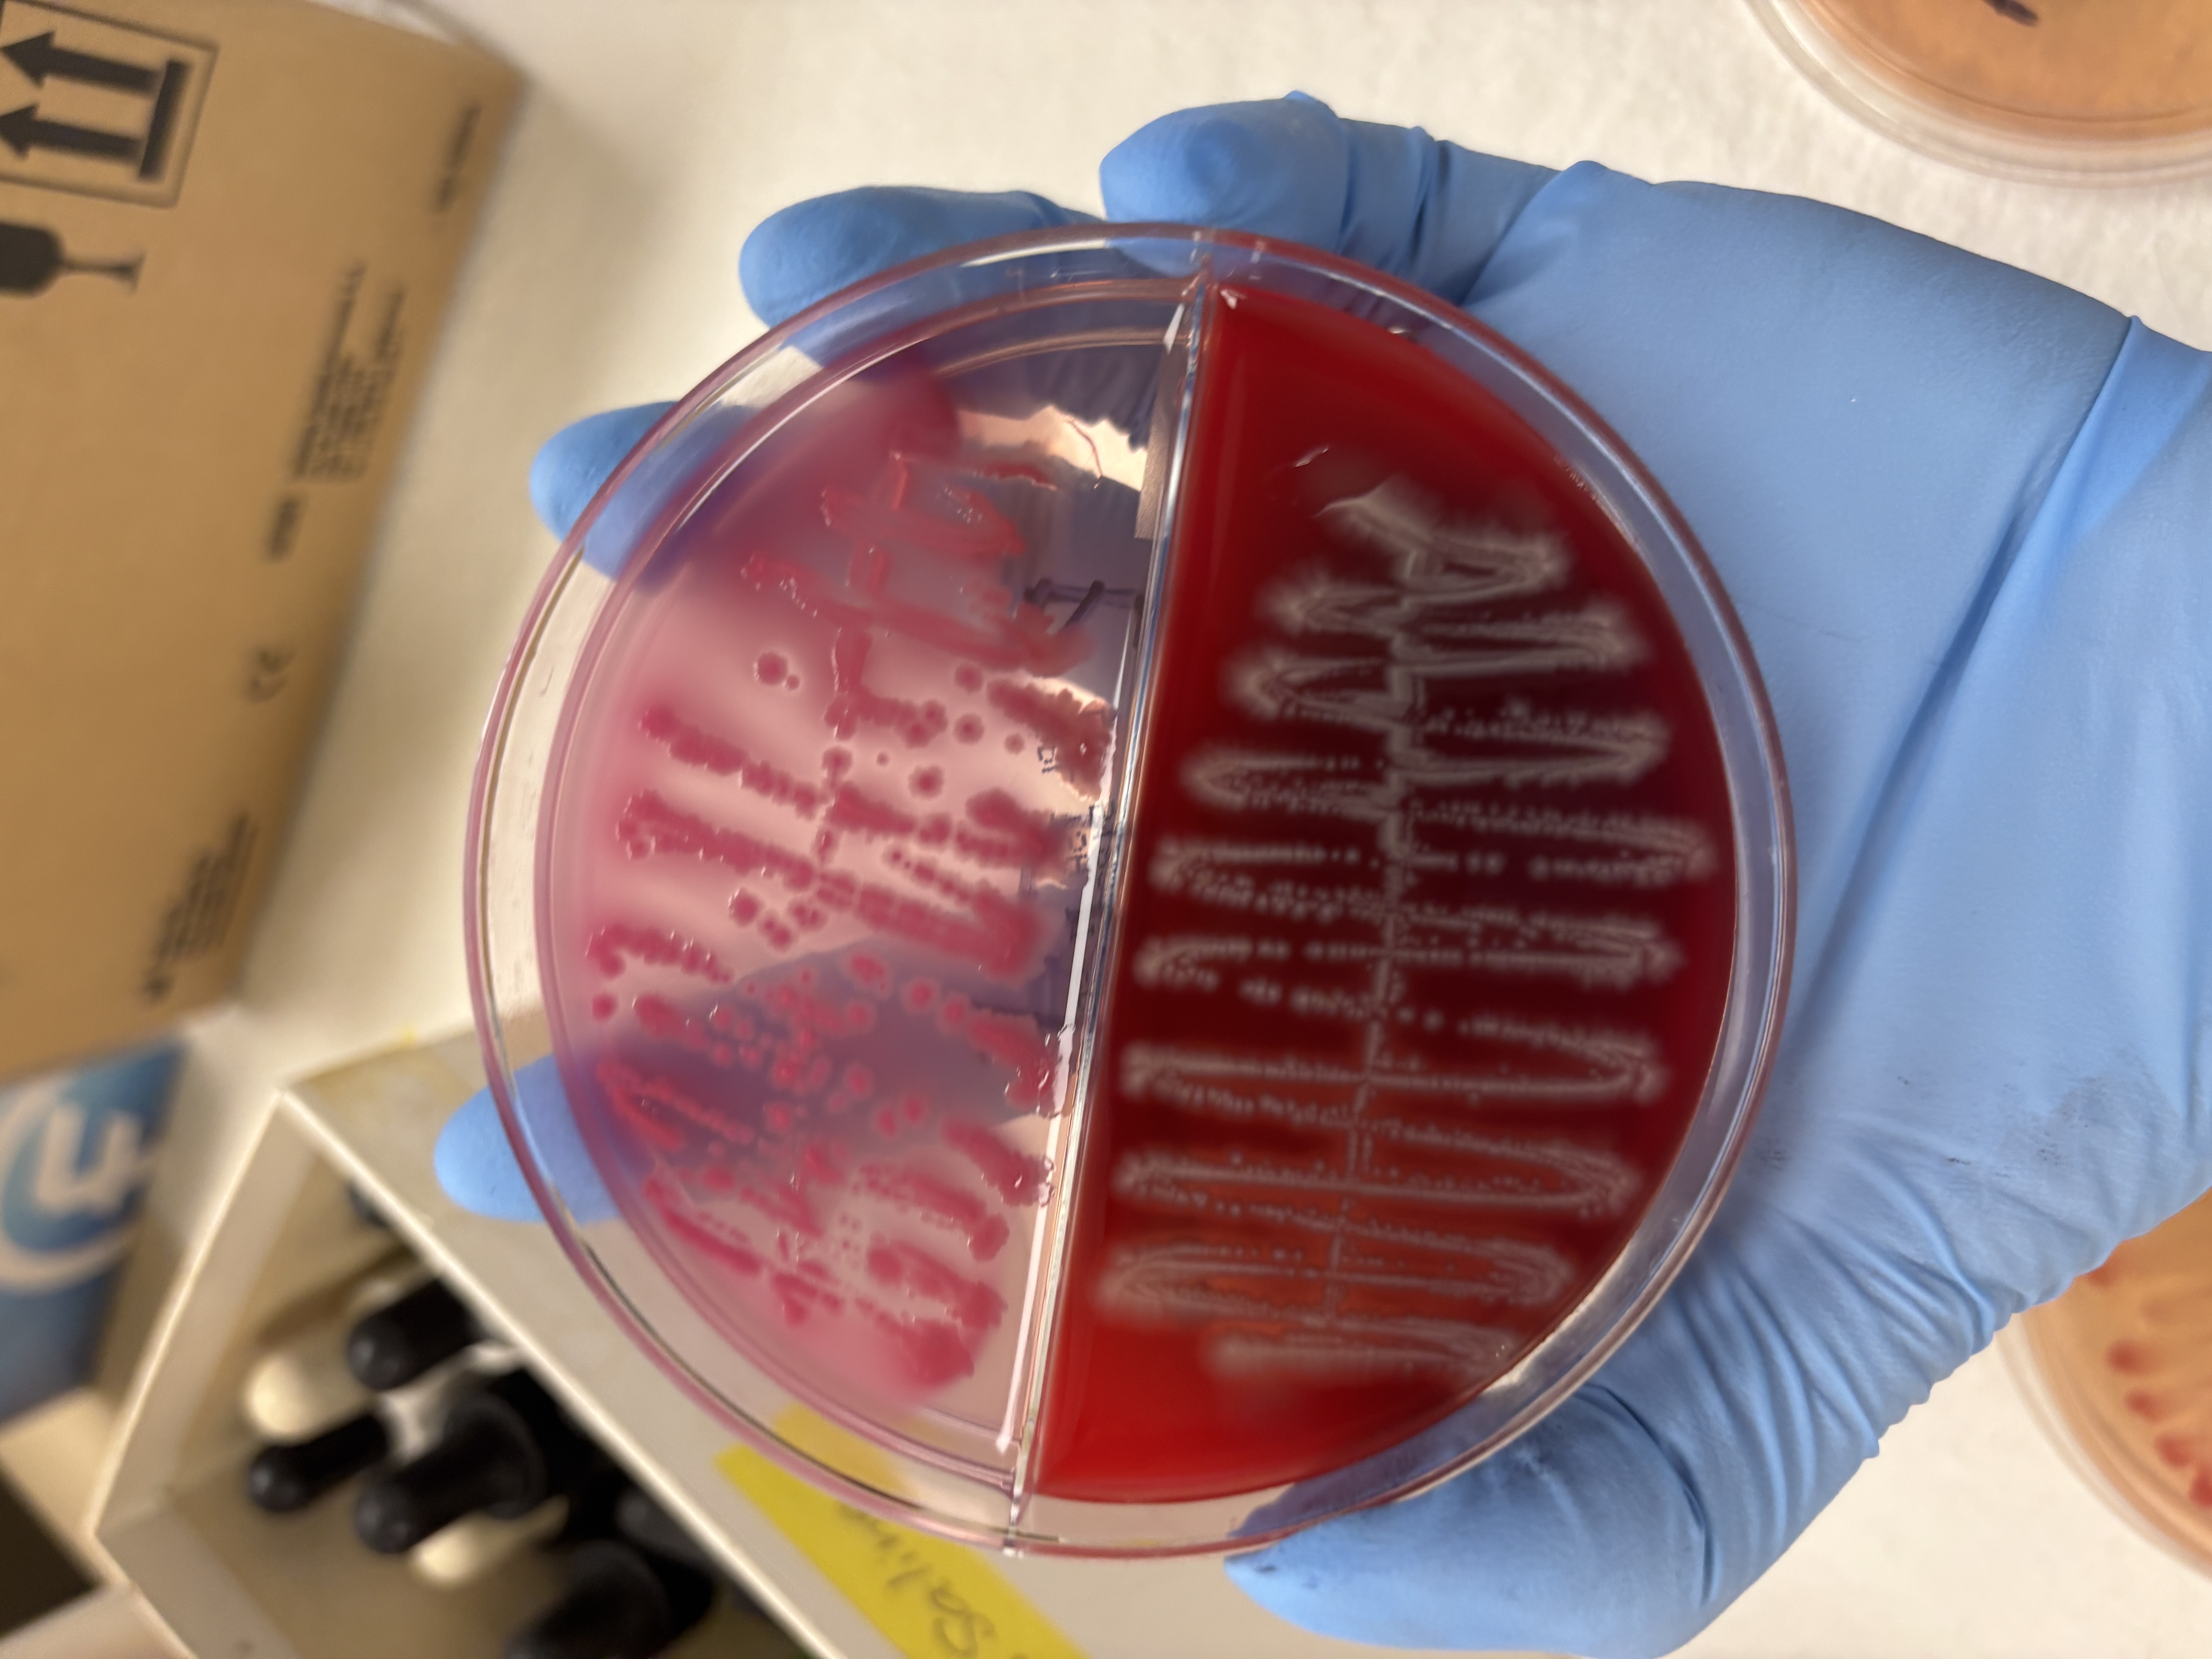
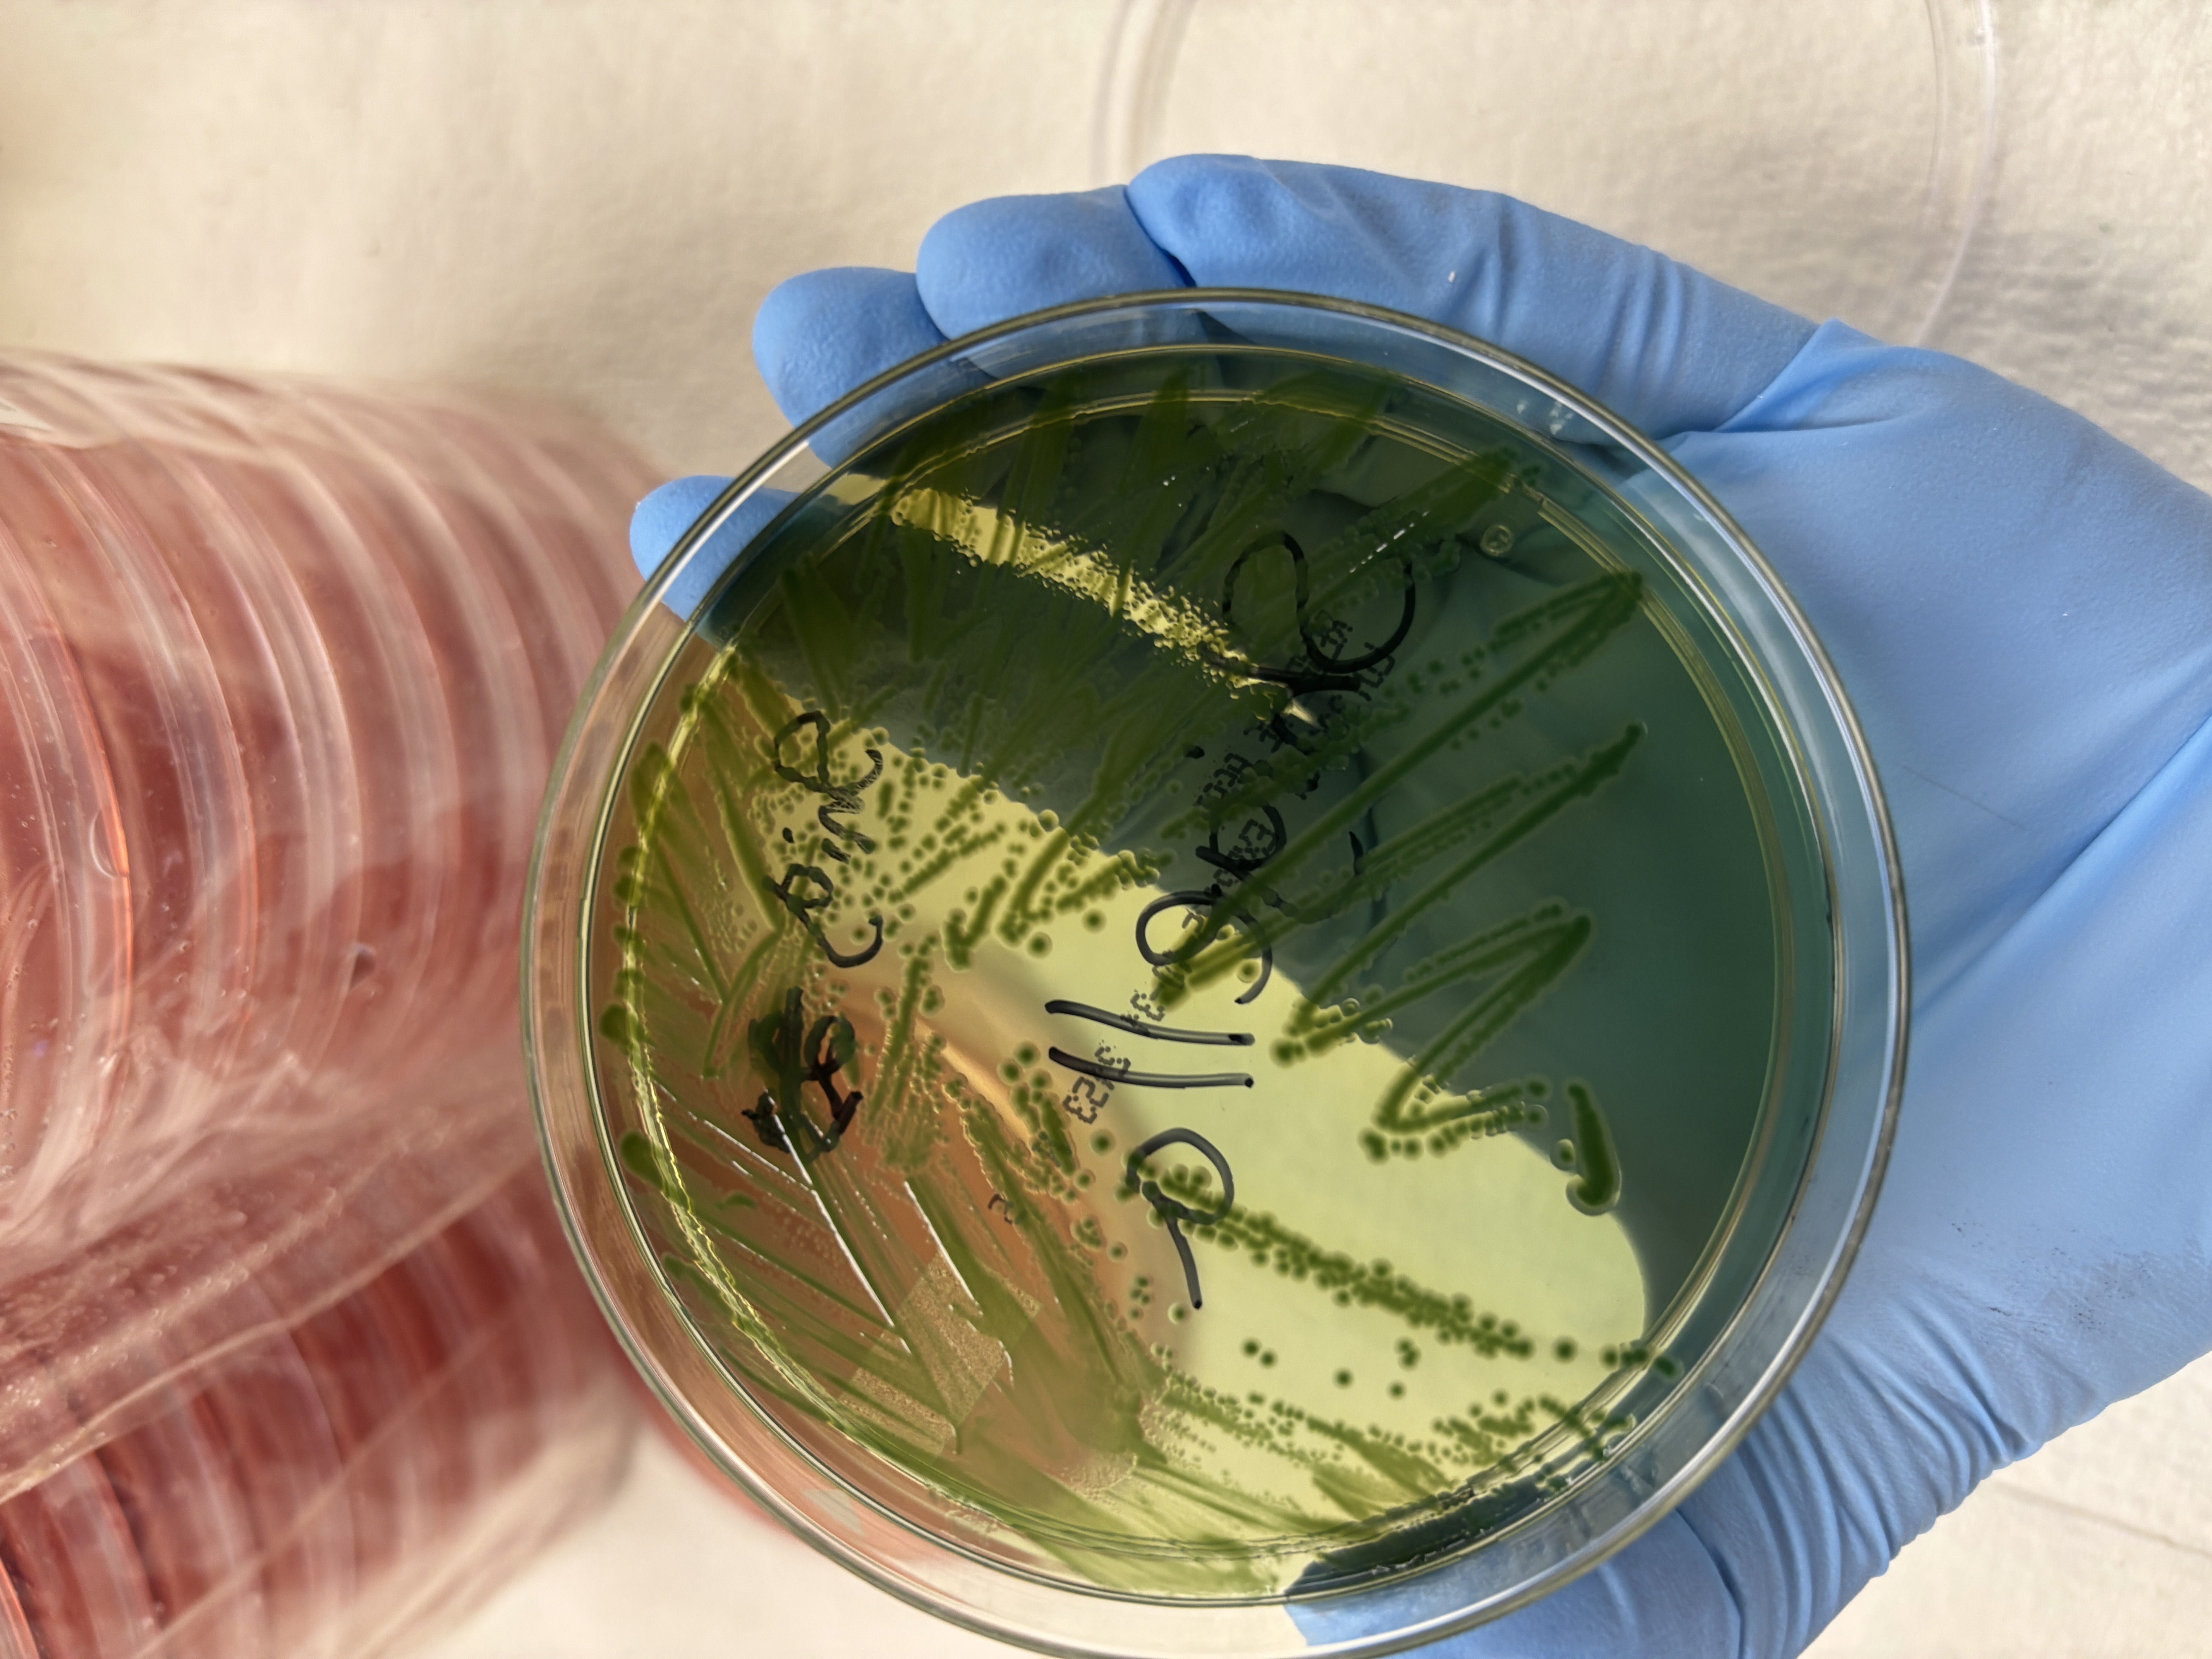
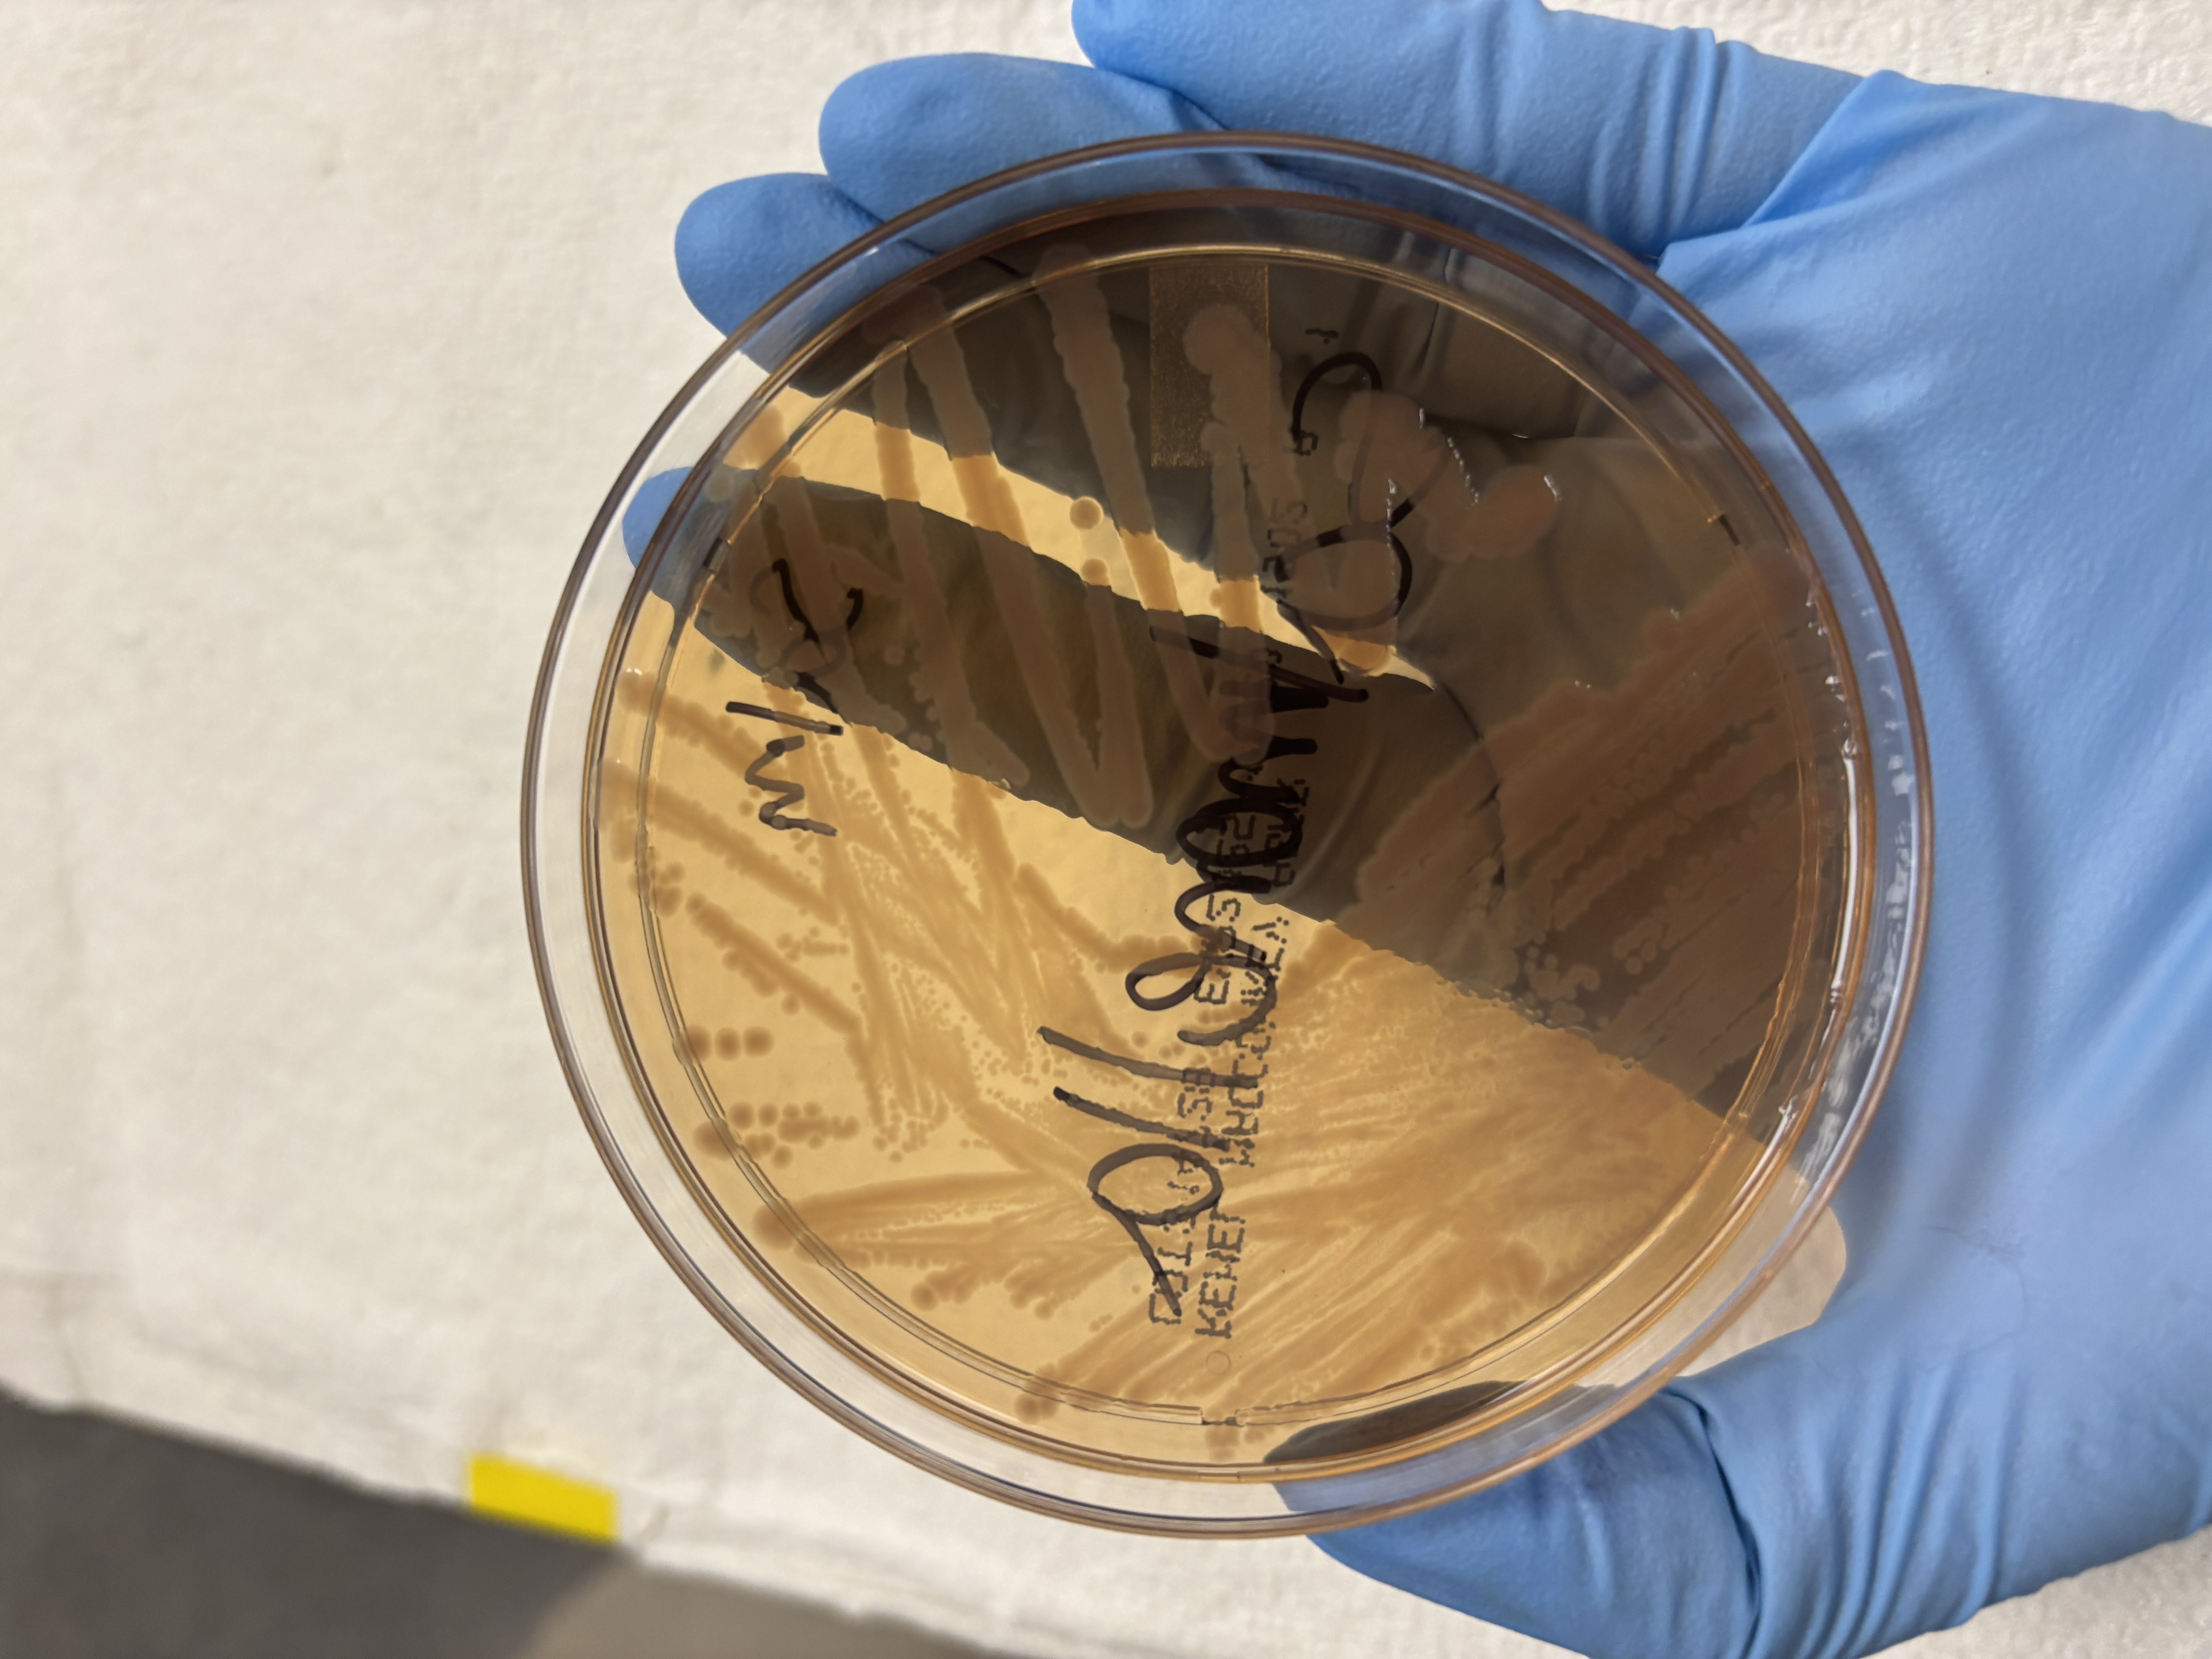
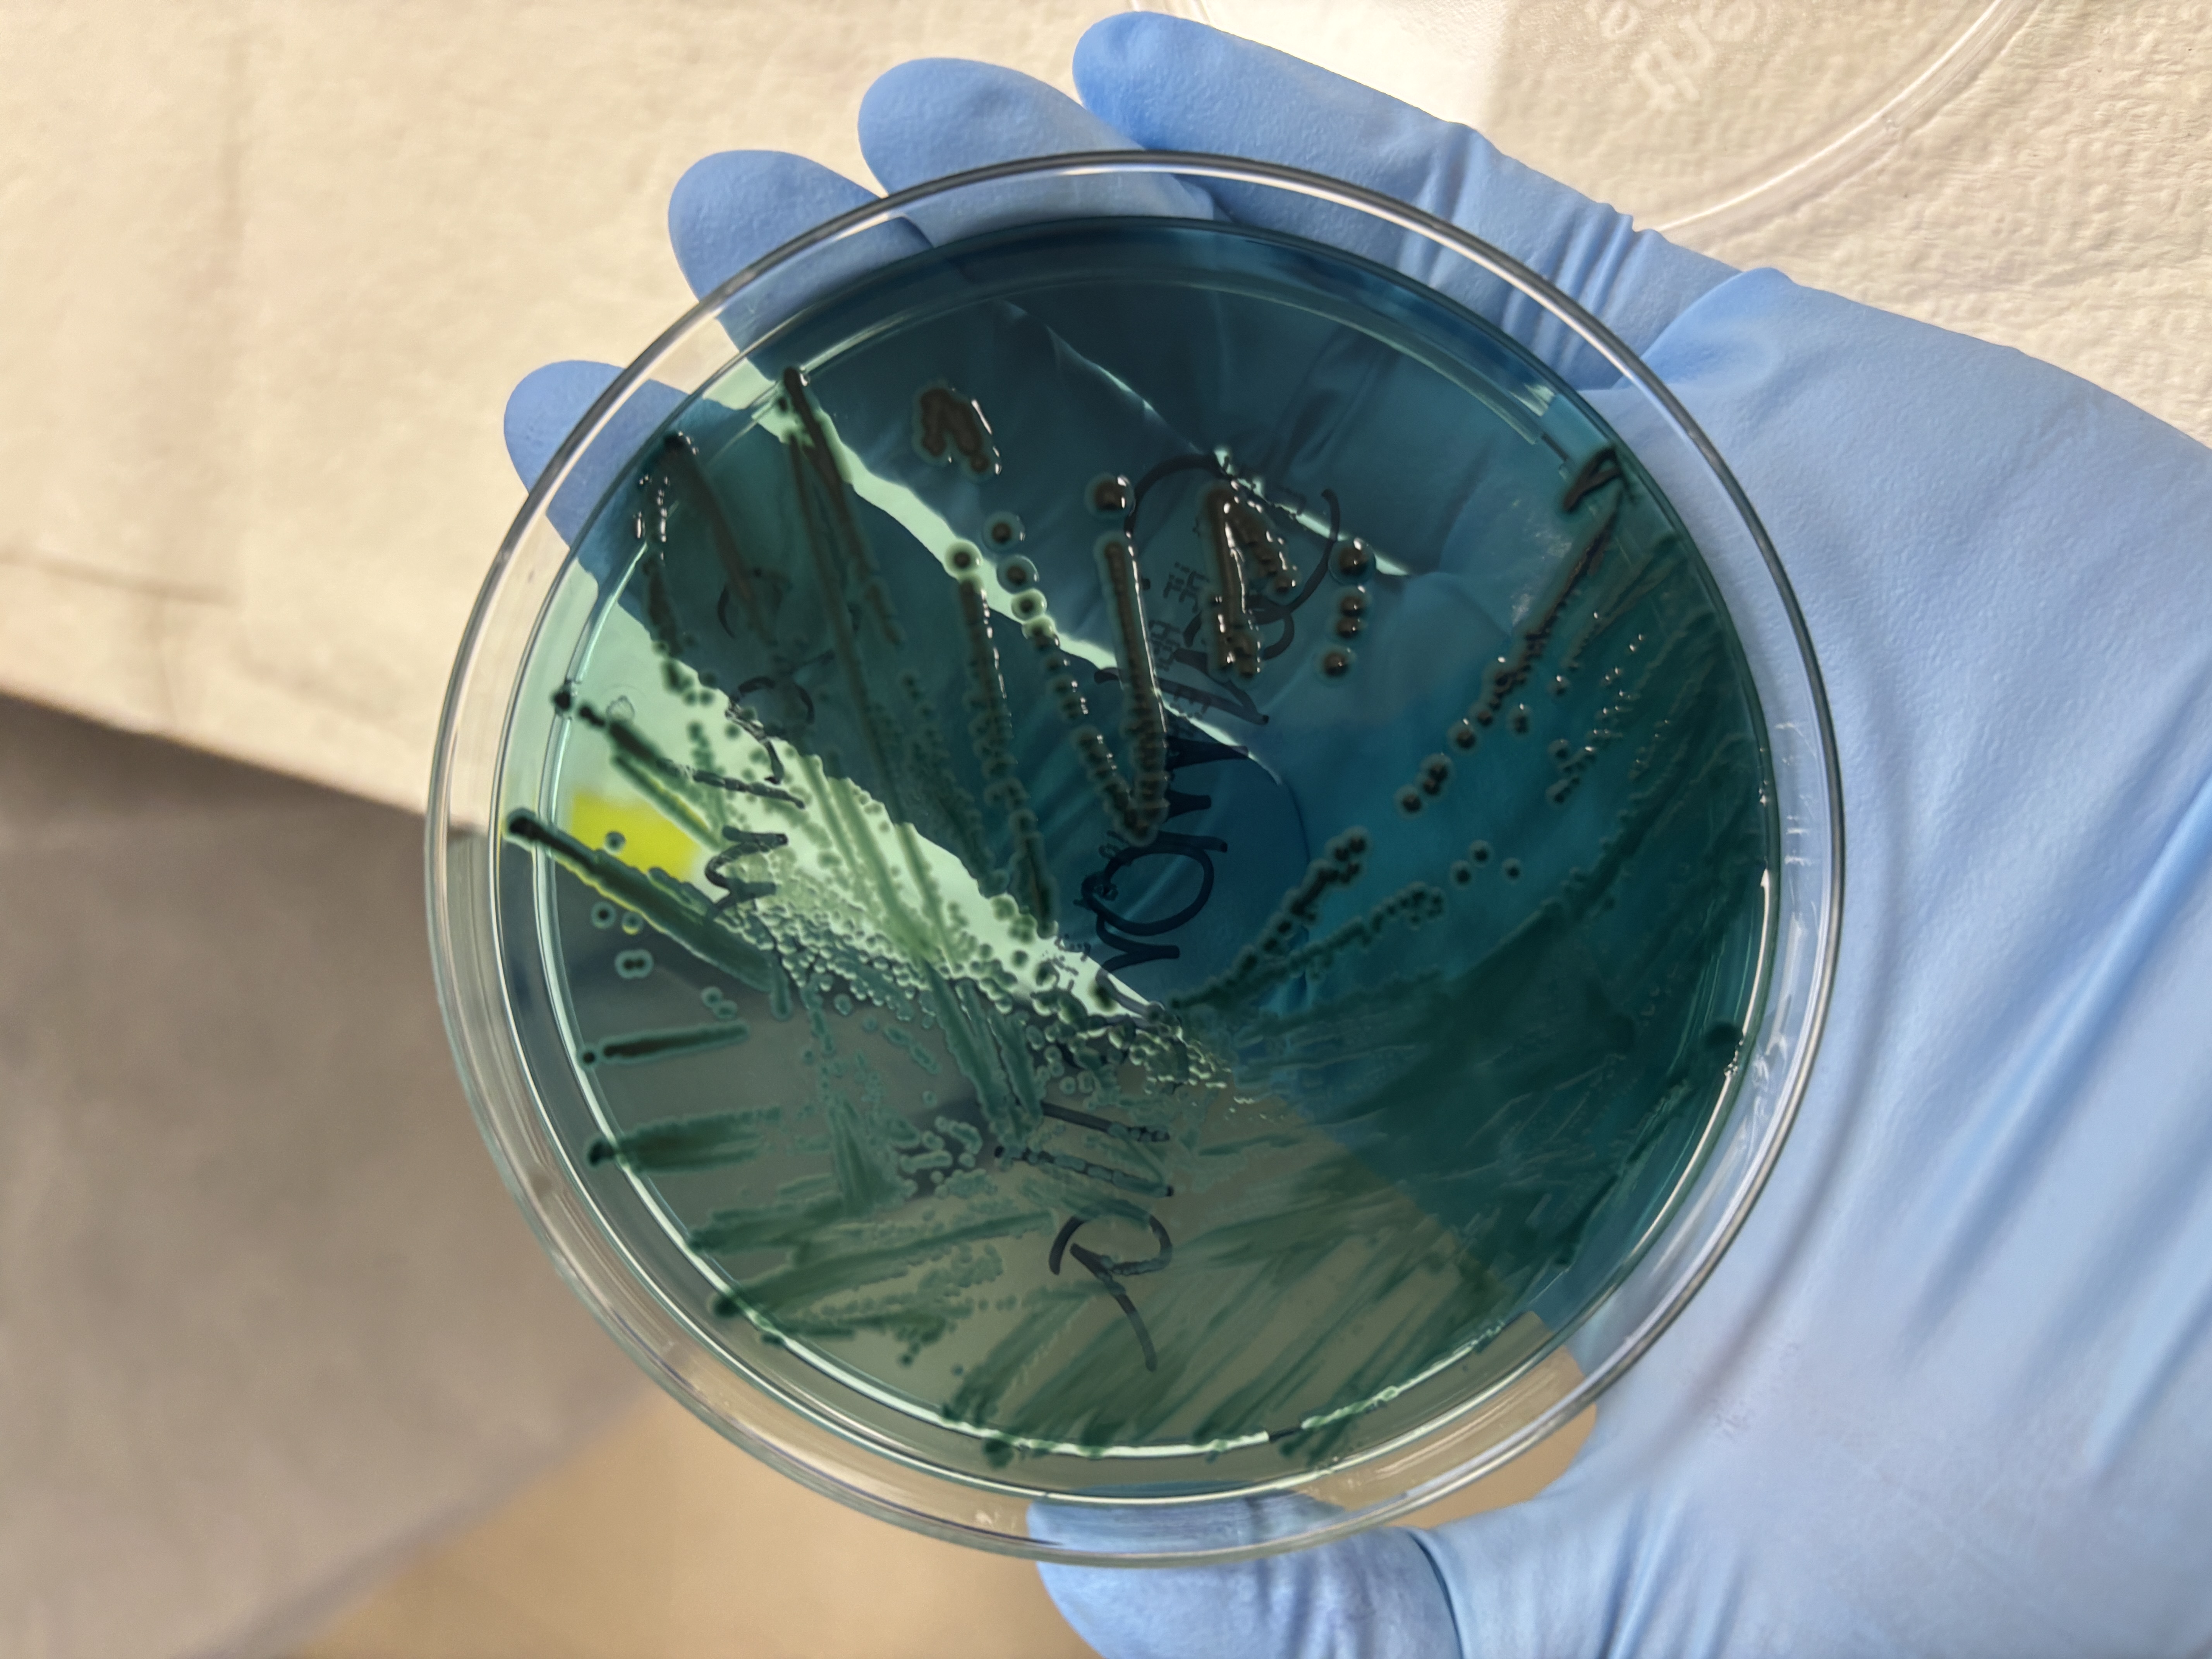
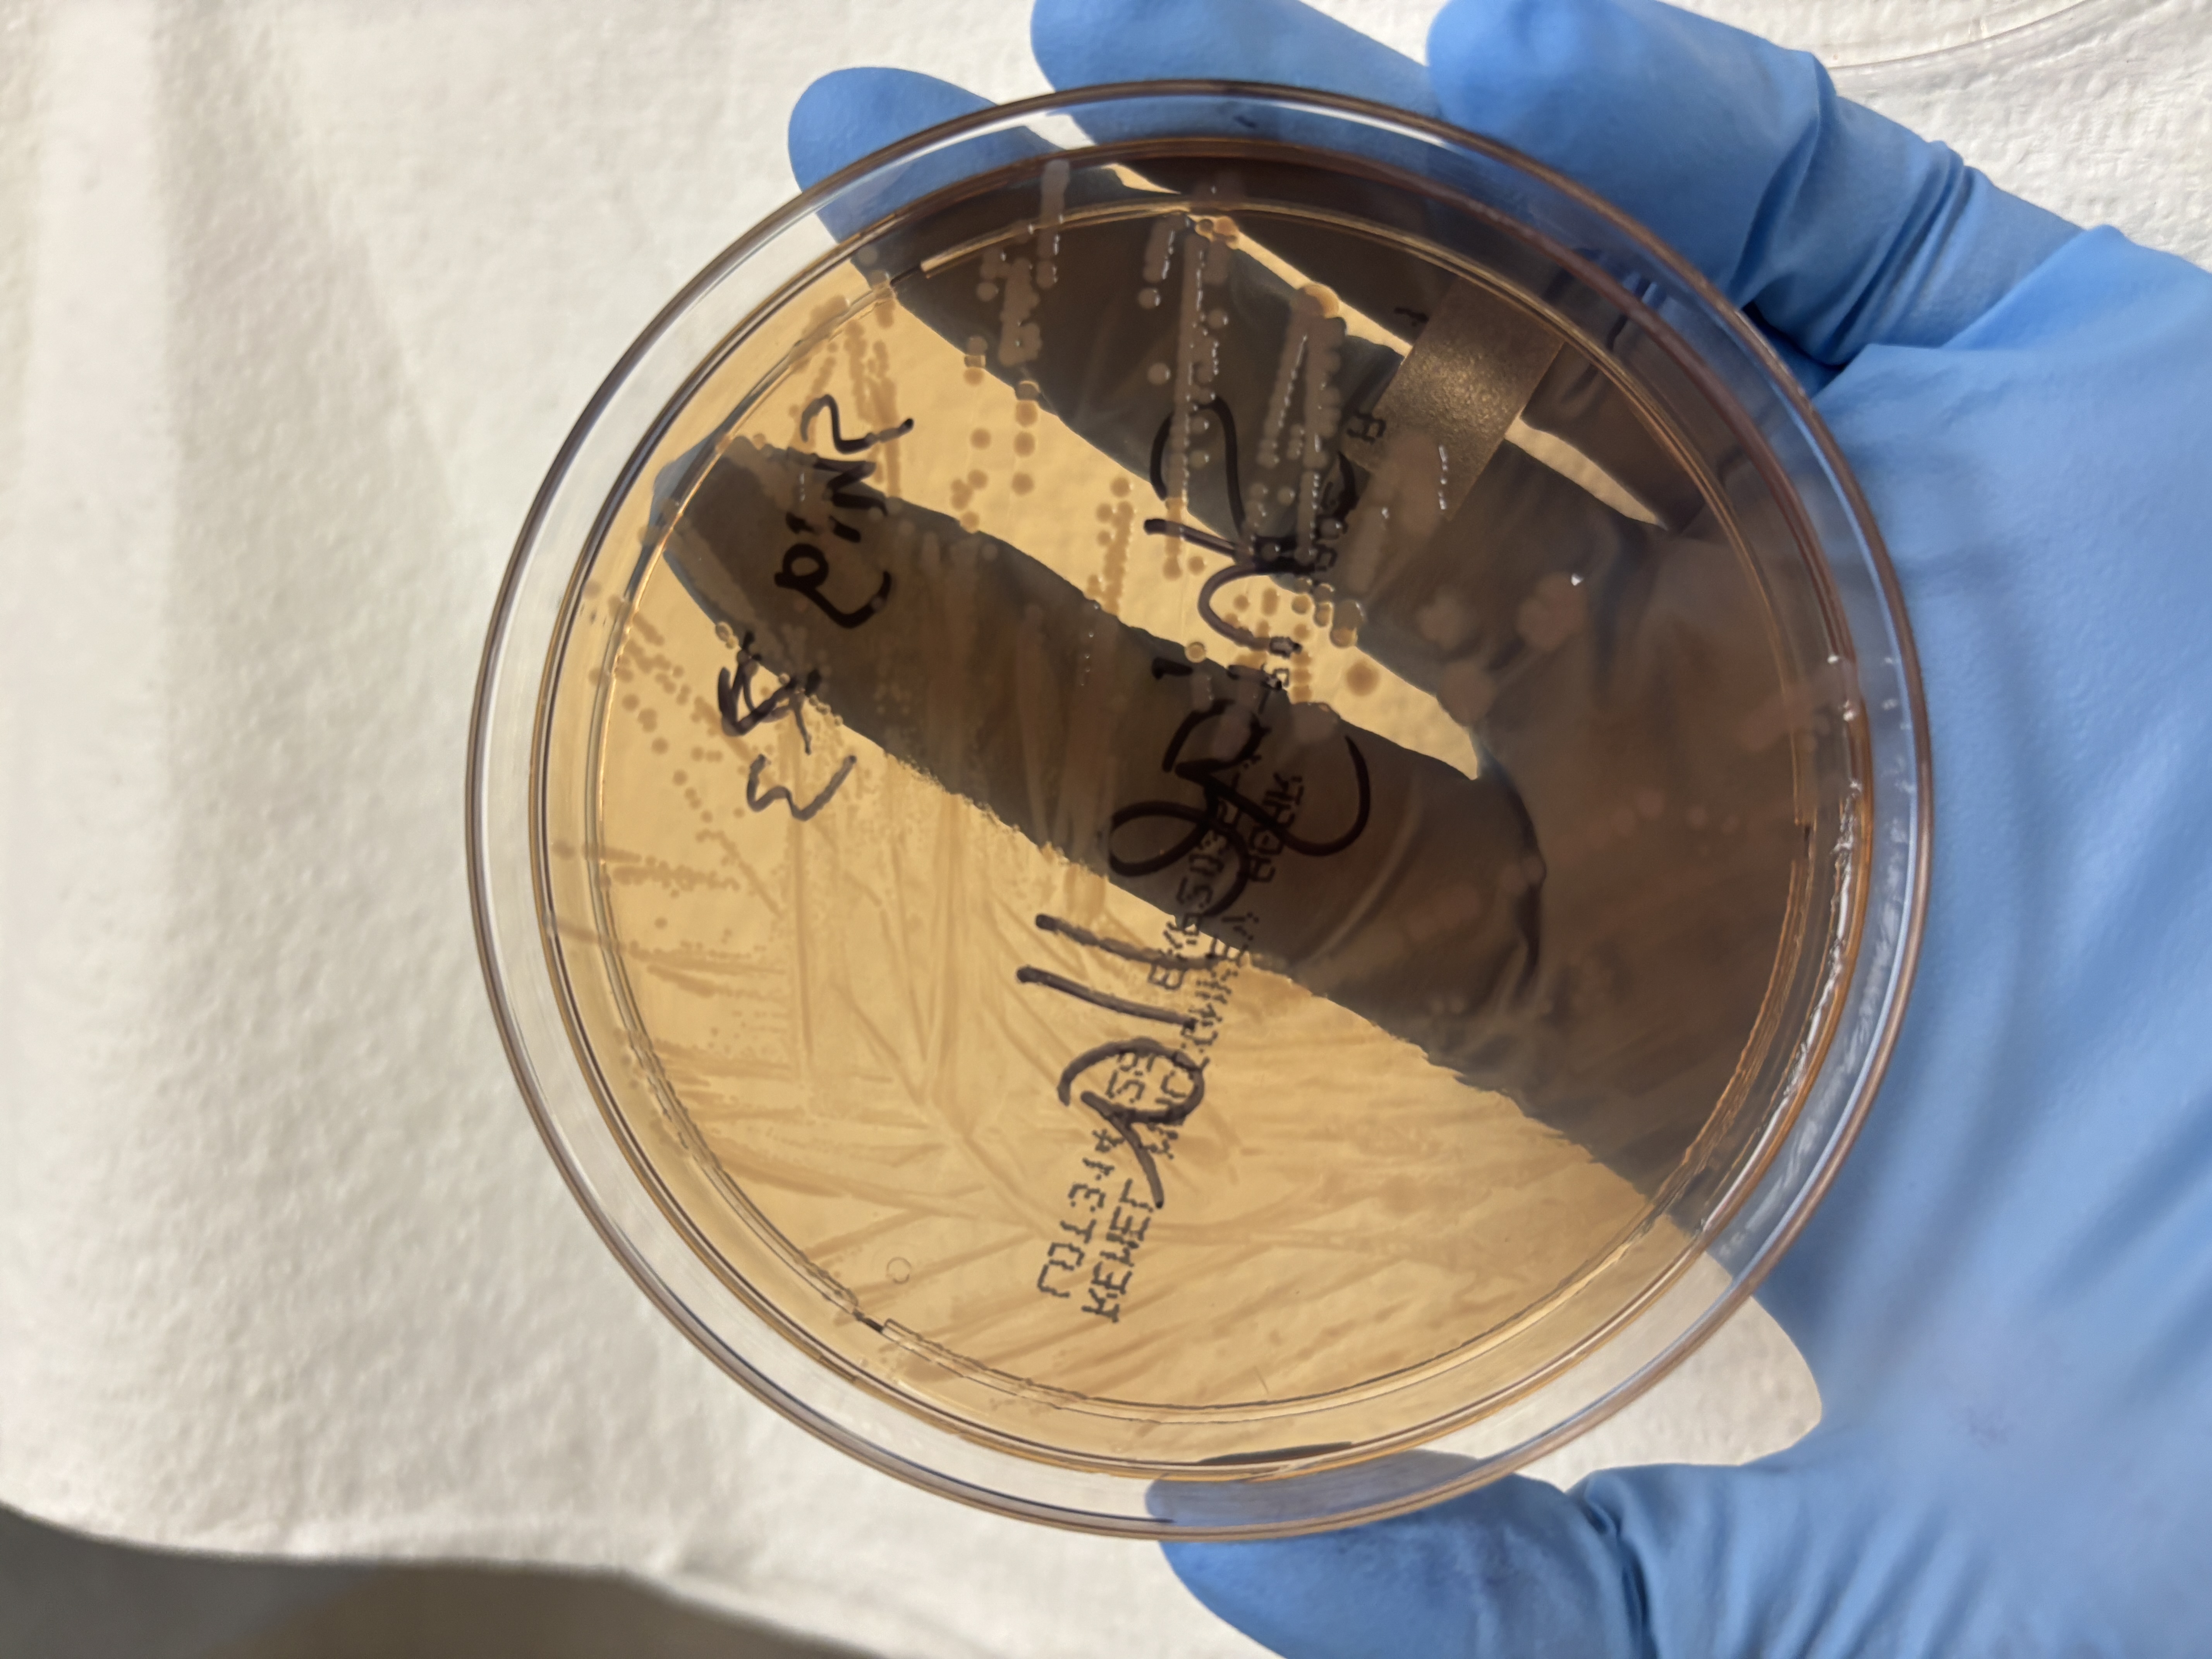

mls micro competency #3
1/59
There's no tags or description
Looks like no tags are added yet.
Name | Mastery | Learn | Test | Matching | Spaced |
|---|
No study sessions yet.
60 Terms
TSI set up
Pick up the center of an isolated colony, stab the butt of the slant and then streak the slant in a zigzag. Incubate with caps loose at 35 degrees celsius in a non-CO2 for 18-24 hours.
Urease set up
Pick up an isolated colony and inoculate onto the agar slant heavily over entire surface. Incubate at 35 degrees celsius in non-CO2 with caps loose loosenned for 18-24 hours.
Citrate set up
Pick up 1-2 colonies of organism and streak the slant then stab the butt. Inoculate with loosened cap aerobically (non co2) at 35 degrees Celsius for 24 hours
Motility test
Pick up an isolated colony and stab straight down medium halfway down, withdraw the needle along the same line of inoculation. Icubate tube at 35 degrees celsius in non-CO2 with loosened cap for 18-24 hours.
Aerococcus
Gram positive cocci, alpha hemolytic, catalase negative, PYR and NaCl positive, LAP negative. White dot in center of very small colonies.
Aerococcus
Strep pneumoniae
Gram positive cocci, alpha hemolytic, catalase negative, P disc (optochin) susceptible. Colonies are mucoid.
Strep pneumonia
TSI: alkaline slant (red)/no change
K/NC- no glucose, lactose or sucrose fermentation
TSI: acid slant (yellow)/acid butt (yellow)
A/A- glucose, lactose, and sucrose fermentation.
TSI: Acid slant (yellow)/acid butt (yellow) with gas
A/AG- Glucose, lactose and sucrose fermentation and gas producing
TSI: Alkaline slant (red)/acid butt (yellow)
K/A: Only glucose fermentation
TSI: Alkaline slant (red)/acid butt (yellow) With H2S
K/A with H2S- there is glucose fermentation and H2S production
LIA: Alkaline (purple)/Acidic (yellow)
K/A- lysine negative and glucose fermentation
LIA: Alkaline (purple)/ alkaline (purple)
K/K- lysine positive
LIA: Red/ acidic (yellow)
R/A- deamination of lysine and glucose fermentation
Urease positive
Hot pink slant or the whole tube
Urease negative
No change in the tube color (yellow)
K/A with gas and H2S
Salmonella TSI
K/K with gas and H2S
Salmonella LIA
Negative
Salmonella urease
K/A
Shigella TSI and LIA
Negative
Shigella urease
K/AG and H2S variable
Proteus TSI
K/A with H2S
Proteus LIA
Positive
Proteus urease
A/AG
Klebsiella pneumoniae TSI
Indole negative, MR negative (variable), urease positive, motility negative
Klebsiella pneumoniae
Indole positive, MR positive, urease negative, motility positive
E. Coli
A/AG
E. Coli TSI
Indole negative, MR positive, urease variable, motility positive
Citrobacter
A/AG with H2S
Citrobacter TSI
Indole positive, MR positive, urease positive, motility positive
Proteus vulgaris
K/AG and H2S variable
Proteus vulgaris TSI
Indole negative, MR positive, urease positive, motility positive
Proteus mirabilis
K/AG and H2S
Proteus mirabilis TSI
Colony morphology of proteus
MAC: flat, NLF BAP: thin film of swarming growth
Colony morphology of klebsiella
MAC: large, mucoid and lactose fermenter BAP: non-hemolytic, gray, mucoid
Colony morphology of E. Coli
MAC: flat, dry lactose fermenter BAP: beta or non-hemolytic gray colonies
Colony morphology of pseudomonas
MAC: flat, NLF, may be mucoid BAP: flat, irregular edge, gray green with silver sheen, beta hemolytic, can be mucoid. Odor: corn tortilla chips or over ripe grapes
Pseudomonas biochemical tests
Oxidase positive, catalase positive, TSI K/K silver sheen, motility top layer positive, growth on cetrimide agar- pigment is pyocyanin, growth at 42 degrees celsius, OF glucose positive
Acceptable urine culture
Shows significant colony counts of pathogenic organisms, and correlates with clinical symptoms
Contaminated urine culture
Shows mixed growth or evident nonpathogenic organisms
Quantitate using 10 microliter loop
Multiply the colony count by 100 cfu/ml
Klebsiella pneumonia
Proteus mirabilis

Klebsiella aerogenes
Serratia
Citrobacter freundii
Proteus vulgaris
Enterobacter cloacae
Pseudomonas
E. Coli
Shigella on HEK
Salmonella on MAC
Salmonella on HEK
Shigella on MAC
Shigella LIA

Proteus mirabilis LIA

Salmonella LIA
